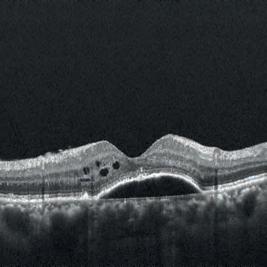

An upskilling workforce: the changes affecting pathways into independent prescribing -
How the end of practice ownership led to a new beginning for one optometrist -

Stepping into the shoes of a hospital optometrist

An upskilling workforce: the changes affecting pathways into independent prescribing -
How the end of practice ownership led to a new beginning for one optometrist -

Stepping into the shoes of a hospital optometrist
Exploring experiences of failure as stepping stones for success










What do our experts say about Sterileyes®


 Adam Sampson
Adam Sampson

“Ever tried. Ever failed. No matter. Try again. Fail again. Fail better.”

It has taken a few decades for Samuel Beckett’s obscure aphorism (has anybody actually read Worstward Ho?) to become the stuff of t-shirt slogans, but for all its clichéd status, it expresses a truth. We readily celebrate success, but give little time for its bedfellow, failure. However, as this edition of OT argues, failure is nothing to be ashamed of, but something, if not to celebrate, at least to learn from. OT is not alone in exploring this topic: last year, the journal Nature underlined its belief that negative experimental results were just as important as positive ones by publishing a collection of examples.
As a non-scientist, I have my own take on the value of failure. Like many others, my career has been a litany of setback, interspersed with the occasional success (usually due to other people’s efforts). If the mistakes have become rarer in recent years, it is because I have learned how to avoid my more egregious errors, if only by surrounding myself with people who balance my excesses. Not hiding from them, but staring my failures in the eye to see what I can learn from them is one of the most useful skills I have acquired. Yes, it is the second half of Beckett’s motto that, for me, matters the most – the willingness to take risks and to try again. And that is not just a skill that is difficult for an individual to acquire; it is also one that many organisations struggle to tolerate.
One of the features of government over the past few decades has been the growing intolerance exhibited to those who have failed. Seeing their colleagues publicly cut apart, it is little wonder that so many civil servants do as little as possible to attract attention. Action risks failure and failure leads to punishment; therefore, take no action. It is not to say that all risk is good risk and all failure is honourable failure. Optometry is an evidence-based discipline, and no optometrist is entitled to take cavalier risks with people’s sight. But, like my career, science advances by trial and error. That is the reality which this edition of OT seeks to explore.
553 miles (/ = 0
 Adam Sampson, AOP chief executive
Adam Sampson, AOP chief executive

Learning from our mistakes and continuing to grow is essential, writes Adam SampsonAdam and the AOP team covered more than 550 miles travelling by train to attend this year’s political party conferences. Find out about engaging with policymakers on page 88.











OT features a range of expert contributors who share their optometry expertise and insight. Here are some of those who helped us put this edition together
My most memorable moment as an optometrist…
“Finding an ocular melanoma in one of my patients; it shocked me to my core, and it made me realise the responsibility we have to every patient who seeks care from us”

Josie Evans, optometrist and AOP Councillor How I got here, page 24
“Opening the big, brown envelope to find I had passed my professional qualifying exams (most astonishingly the dreaded binocular vision)”
Ceri Smith-Jaynes, IP optometrist and OT clinical multimedia editor IP and me, page 34
OT partners with SpaMedica for a roundtable discussion
Through a virtual roundtable hosted by OT and SpaMedica, we explored with three eye care practitioners: how can private providers support optometrists to enhance the patient experience?
Web content and social media manager: Leah Boyle leahboyle@optometry.co.uk
Clinical editor: Dr Ian Beasley ianbeasley@optometry.co.uk

“Being invited by the AOP to deliver a lecture at 100% Optical about returning to work in practice after a career break. (And indeed delivering the lecture)”
Lizzy Yeowart, optometrist and lifestyle blogger Trend Watch, page 79
Advertising: Sonal Mistry 020 3771 747 sonal.mistry@thinkpublishing.co.uk
Advertising production: aop@ccmediagroup.co.uk
Art director:
October/November 2023
Volume 63:05 Issn 0268-5485
ABC certificate of circulation
1 January 2022–31 December 2022
Editor: Emily McCormick emilymccormick@optometry.co.uk
Deputy editor: Lucy Miller lucymiller@optometry.co.uk
Features editor: Selina Powell selinapowell@optometry.co.uk
Senior reporter: Kimberley Young kimberleyyoung@optometry.co.uk
Clinical editor for multimedia: Ceri Smith-Jaynes cerismithjaynes@optometry.co.uk



Video production editor: Laurence Derbyshire laurencederbyshire@optometry.co.uk
CPD enquiries: 020 7549 2076 CPDhelp@optometry.co.uk
AOP membership and OT subscription team: subscriptions@aop.org.uk
Grant Pearce
Associate director: Anna Vassallo
Executive director: Jackie Scully
Published bimonthly for the Association of Optometrists by Think Media Group 20 Mortimer Street, London, W1T 3JW
Printed by Acorn Web, Normanton Ind Estate, Loscoe Close, Normanton, West Yorkshire, WF6 1TW
All rights in and relating to this publication are expressly reserved. No part of this publication may be reproduced in any form or by any process without written permission from the AOP or the publisher. OT and its wrapper are produced on paper from European mills meeting the highest quality and environmental standards. The journal and paper wrapper are fully recyclable.
UK'slargestproviderof NHScataract surgerywith 50 hospitalsin the UK
Referralto treatment time of 4-8 weeks
Freetransport for patients

Patientsreturnto community optometrists for post-op assessment
SCANTHE QR CODETO FIND OUT MORE:


Regularcommunicationfrom SpaMedicaat everystage of the patient journey
Specialistadviceto community optometrists to support you with your patients/referrals
24-houremergencyhotline for your patients
Togetherwe providegreatoutcomes; ultimatelyimprovingour patients'qualityof life
Keep up-to-date with all things optics by following OT’s social channels


OT’s deputy editor, Lucy Miller, and video production editor, Laurence Derbyshire, visited the newest practice of R Woodfall. It is the sixth practice for the group www.optometry.co.uk/videos
OT’s deputy editor, Lucy Miller, and video production editor, Laurence Derbyshire, spent the day shadowing Specsavers domiciliary optometrist, Kejal Shah. During the drivealong they visited eight patients, observing the role that a domiciliary optometrist plays www.optometry.co.uk/videos
Read our latest content, updated daily online: www.optometry.co.uk
OT travelled to Birmingham to film with Sònia Travé Huarte, a postdoctoral researcher at Aston University, She will deliver OT’s next interactive CPD video
www.optometry.co.uk/cpd
OT’s senior reporter, Kimberley Young, received a demonstration of Jai Kudo’s latest development. The event featured an immersive virtual reality experience www.optometry.co.uk

1
OT has released four online modules for the practice team. www.optometry.co.uk/ practiceteamtraining
2
As the UK media partner for 100% Optical, OT has launched an online hub about the show www.optometry.co.uk/100optical
3
OT’s new Clinical interpretation exams share cases through images and videos www.optometry.co.uk/cpd


4
Our Practice Team Guide
Read OT’s latest Practice team guide, created with JJV www.optometry.co.uk/ practiceteamguide


OT talks with optical leaders about their approach when things do not go to plan – and how mistakes have shaped their success

WORDS: SELINA POWELL


PHOTOGRAPHY: MARK NEWTON

You may not have heard of the newspaper cartoonist fired from the Kansas City Star for a lack of imagination. Or the budding performer who received this evaluation at an early screen test: “Can’t act. Slightly bald. Can dance a little.”
Yet these experiences of failure shaped Walt Disney and Fred Astaire in the same way that their successes made them household names.
“Failure is success in progress,” the Nobel prize winning physicist (and high school dropout) Albert Einstein once said.
For this edition, OT asked leaders within optics for their approach to failure and how the times things did not go to plan have informed their success.

From the age of 14, Stephanie Lipsey-Liu imagined owning her own optometry practice.


She pictured a boutique building with a large glass shopfront and a grand piano in the corner. Her three labradors would make themselves at home on the practice floor.
Fast-forward two decades, and the reality is slightly different from the dream.
Lipsey-Liu became the owner of Charles Lea Opticians in Mapperley alongside her business partner in October 2021.
She has two rescue dogs rather than a trio of labradors. The closest she comes to a grand piano is playing the occasional tune for care home residents as part of her domiciliary eye care business.
Although the details of practice ownership may not be exactly as she imagined them, Lipsey-Liu still has a child-like joy in the fact that she owns her own business.
“I can’t actually believe it is my practice. Every time we drive past the
practice with my daughter I go, ‘Say hi to mummy’s practice.’ We say hi to it all the time,” she said.
Lipsey-Liu’s experience as a locum before practice ownership has helped her to reflect on what does and does not work in practice. Through hearing gossip circulating when she first started locuming, Lipsey-Liu learned the importance of valuing staff. “Being flexible with their needs and acknowledging their contribution is essential,” she said.
When things do go wrong in practice, Lipsey-Liu is an advocate
Don’t dwell on the past if you’re not learning from it
Stephanie Lipsey-Liu
for kindness – to her staff, to patients and to the person looking back from the mirror.
“We are so much harder on ourselves than on anyone else. If you catch yourself saying something to yourself that you wouldn’t say to any other person, then stop,” she emphasised.
“Don’t dwell on the past if you are not actually learning from it,” she said.
Lipsey-Liu’s six-year-old daughter is now thinking about her own future plans. Optometrist is on the list – but it sits alongside a singer, a dancer, a zookeeper and a ballerina.
“She believes she can do it all,” Lipsey-Liu shared.
Optometrist and practice owner, Deepak Oberai, describes himself as an “accidental entrepreneur.”
In 2012, after six months of working without payment for a practice owner who was short of funds, Oberai suggested that the owner sell him the business.
“When I look back, I think, ‘What a silly, dumb move.’ But when you are in your 20s, you do things that don’t make sense. Ultimately, I’m so glad that I did,” he shared.
Two years into business ownership, the practice was not making money and Oberai reached a point where he considered closing the doors.
Oberai came up with an unlikely solution to these challenging circumstances. He would climb Mount Kilimanjaro – and he would do it in two months’ time.
“Everyone was saying that it was not going to happen but two months later, I was on top of the highest mountain in Africa,” he shared. Oberai explained that overcoming this test of endurance proved to himself that he could grapple with the equally daunting struggles of business ownership. He gained a sense of perspective, both literally and figuratively.
When Oberai returned from Mount Kilimanjaro, he decided to stop working as a locum alongside business ownership and focus his
energy on transforming his practice. He refurbished the building, hired a dispensing optician and reduced the eyewear selection from close to 1000 mostly NHS-value frames to a carefully curated display of 30 frames.
“People would walk in and the first thing they would say is, ‘Wow, where am I?’,” Oberai recalled.
Within three years, the practice turnover had doubled. After building momentum in his first practice, Oberai looked to embark on a new challenge with the purchase of a second practice.
He visited optometry practices in Belgium, Germany and France to find inspiration for what he wanted his new venture to become.

In the process of establishing Station Road Opticians, Oberai learned the importance of a business reflecting the neighbourhood that surrounds it.

“We are not in Berlin. We are in a suburb of Manchester. We needed to match what people are here for,” Oberai shared.
In terms of mistakes in the frames he stocks, Oberai is resigned to the fact that around one in 10 frames will not be a popular purchase – but they may still make a customer smile or start a conversation.
There is a limited-edition frame from Silmo that has sat on the shelf since it was purchased.
“ My life is so much more fulfilled with all of the skills that I have learned Deepak Oberai
“It reminds me of decisions that I have made in the past. I think one day, maybe in five years’ time, some guy or girl is going to walk into the practice and think, ‘That frame is for me.’ It will make me very happy,” Oberai shared.
He observed that owning a business is a process of constant improvement. Oberai believes that it is a mistake to think that an optometrist’s education ends at qualification.
“So many doors can open after you have qualified,” he said.
“In the early days of Station Road, I had those regrets of wondering why I had taken on this challenge – was it too big? But now, five years in, I look back and my life is so much more fulfilled with all of the skills that I have learned,” Oberai shared.

Conor Heaney is the owner of Jones & Co Styling Opticians in Manchester.
He is also the founder of Optical Success Academy, which provides
marketing and business coaching to independent optometry practices.
Heaney’s podcast, The Optical Entrepreneur, garners wisdom from a diverse range of industries and professions to help optical professionals grow.


Alongside optical industry stalwarts, he interviews experts in sports retail, airline hospitality and restaurant service.
“It is logical if you think about it – if you want to offer good service, then consider what other businesses do this well,” he shared.
Reflecting on failure within his own experience of establishing a business, Heaney shared that most things he experimented with did not work at first.
“You have to persist and figure it out. You make refinements and then it turns into something that you wouldn’t go back on in a million years,” Heaney emphasised. He shared that the skills necessary in business are often different from those that are honed as an optometrist.
“When you study optometry, there is an exactness and a preciseness to it. You know what the prescription is or what the diagnosis is,” Heaney shared.
“In business, I think you
The most successful people learn to use their mistakes and not fear them Conor Heaney
tUsing measuredandmodeleddata,pooledacrossages(8-17), MiSigh~ 1 dayslowedmyopiaprogressionby anaverageof approximately50%. ,1 2 monthspost-treatment,evidenceindicatesthat noaccumulatedmyopia controlbenefitswerelostfollowing3 or 6-yearsof MiSight®1 daywear(on average,for childrenaged8-15 at start of wear).Instead,eyegrowth revertedto expected,age-nonmalrates.
1, Arumugam8 et al.ModellingAgeEffectsof MyopiaProgressionfor the MiSight1 dayClinicalTrial.Invest.OphthalmolVisSci.2021; 62(8): 2333. 2, ChamberlainPet al.A 3-year RandomizedOinicalTrialof MiSightLenses for MyopiaControl.OptomVisSci.2019; 96(8): 556-567. 3, ChamberlainPet al.Long-termEffectof Dual-focusContactLenseson MyopiaProgressionin Children:A 6-year MulticenterClinicalTrial.OptomVisSci.2022; 99(3): 204-212. 4. ChamberlainPet al.Myopiaprogressionon cessationof Dual-Focuscontactlenswear:MiSight1 day7-year findings.Optom VisSci.2021; 98(E-abstract):210049. 5. ZadnikKet al.FactorsAssociated w~h RapidMyopiaProgressionin School-agedChildren.Invest.Ophthalmol.Vis.Sci.2004; 45(13): 2306. 6. HammondD,ArumugamB,et al.MyopiaControlTreatmentGainsareRetainedafterTerminationof Dual-focus ContactLensWearwith no Evidenceof a ReboundEffect.Optom VisSci.2021; 98(E-abstract):215130.





© 2022 CooperVision.CooperVision®andMiSight®areregisteredtrademarksof TheCooperCompanies,Inc.andits subsidiaries.



CVGY122291-1

often have to make decisions with the best information that you have. You have to be willing for mistakes to happen,” he emphasised.
Heaney believes that a hesitancy to talk about failure is linked to a sense of shame.
“The reason people don’t talk about their failures is that they are afraid of what those mistakes say about them,” Heaney shared.
“But they aren’t anything to be afraid or ashamed of. Everyone makes them. The most successful people learn to use their mistakes and not fear them,” he said.
A formative experience that shaped Jason Kirk’s view of failure was learning how to play chess from his father at the age of four.

“For three years he would beat me at chess, every night. I would play and play and play. He said to me, ‘You have got to learn how to lose before you learn how to win.’ That shaped me so much,” Kirk shared.
Five decades later, Kirk continues to play chess and the strategic thinking at the heart of the board game informs his approach.
After entering optics in 1992, Jason Kirk and Karen Kirk – his wife and creative director – built a successful eyewear brand over two decades.

However, after taking on investors who did not share the same vision in 2012, the Kirks made the difficult decision to sell their shares in the
company. “It is like losing a member of the family because we had built it up from nothing,” Kirk shared.
“When you are faced with that kind of situation, you either lie down and cry, or you say, ‘I know what I am capable of and I am going to get back on the horse and do it again’,” he said.
Kirk & Kirk was established in 2013, launching its first collection in 2015. A creative blend of modern materials and traditional processes has led to a range of ultra-light weight frames in an unprecedented range of colours.
“We are the only people in the world who hand-make frames from acrylic,” Kirk shared.
“They are made the old-fashioned way at our factory in France – there is very little that is modern process,” he said.
A similar thread of innovation ran through the endeavours of Kirk’s grandfather and great uncle, Percy and Sidney Kirk, who began making lenses with a repurposed sewing machine in 1919.
The pair went on to become trailblazers within the industry –inventing the first adjustable nose pad and the bullet proof safety lenses worn by Malcolm Campbell when setting the world water speed record in 1939.
Kirk established his first company after he discovered boxes of original frames designed by his grandfather while helping to refurbish his father’s optometry practice.

When it comes to frame selection, Kirk shared that you can see it in a customer’s expression when they are wearing the right frame.
“Their face lights up. Often, they don’t even need to look in the mirror. They just feel it,” he said.
“If you don’t feel two inches taller when you put the frame on, then you haven’t got the right frame,” Kirk emphasised.
When reflecting on failure within the optical sector, insight can be gained from an institution that deals on a daily basis with both perceived and actual mistakes in optometry practices.
Since 2014, the General Optical Council has funded the Optical Consumer Complaint Service (OCCS) to provide a complaint mediation service.
Reflecting on what makes an effective approach when a mistake is made in optical practice, OCCS head, Jennie Jones, emphasised the importance of listening to the customer.
“One of the most common issues that comes through to the OCCS is how the practice has handled the situation – not the situation itself,” she said.
“In a situation where there has been a mistake, or the consumer believes there has been an error, communication is absolutely at the
“
There is a legacy that continues beyond the business closing down John Pritchard
heart of managing that conflict,” Jones said.
As an initial step, staff should endeavour to understand the customer’s perspective and how they would like the error to be addressed.
“Asking open questions so that you understand where the consumer is coming from shows the consumer that you want to hear them. We all want to be heard when we complain,” Jones shared.
Staff can then move on to explaining why the situation occurred, what is being done to remedy the error and what steps are being taken to ensure that it does not happen again.
Jones emphasised the importance of practice staff keeping a sense of perspective when dealing with complaints.
“We have had complaints escalating through to the OCCS over £5. I get that we all have our principles, but from a practice point of view, it may have been better investing that time and energy in another way,” she shared.
In August, Pala Eyewear founder, John Pritchard, announced his
 Jennie Jones
Jennie Jones
intention to close the sustainable eyewear brand. Since its launch in 2016, a partnership with Vision Action has seen Pala Eyewear support more than 80,000 individuals to receive accessible and affordable eye care in Africa.

Pritchard shared that the B Corp brand is made up of “just two, incredibly passionate but equally exhausted people.”
“We traded for seven years and we are yet to make a profit,” he shared with OT
The business was progressing well at the end of 2019 before sales dropped off during the pandemic. Pritchard described the cost of living pressures that middle income earners are facing as “the final dagger.”
Reflecting on the decision to close, Pritchard shared that he did not see the economic situation improving over the next couple of years.
“It would have continued to put a strain on my financial situation, which would have affected my mental health. I feel like the timing is right,” he said.
Pritchard shared that he views the experience of establishing Pala Eyewear as a learning curve.
“I always said that I didn’t want to be sat in a rocking chair thinking ‘Why didn’t I do it?’,” he said.
“In the purest sense, deciding to close the business could be seen as a black and white failure, but I would argue that the success of Pala can be measured in the legacy it leaves behind in Africa. That will continue
We have had complaints escalating through to the OCCS over £5
long after the business disappears,” Pritchard observed.
Willie Koroma is one of four optometrists working in Sierra Leone – a country with eight million people.
Working in a health system that is drastically underfunded, the challenges can seem insurmountable.

Koroma works at Connaught Hospital in the capital city of Freetown, but each fortnight he will travel to the districts that do not have eye care provision with Vision Action.
“When I go into the field, it can make me become emotional because sometimes we can’t provide solutions to the problems,” he said.
“There are people going needlessly blind,” Koroma shared.

He will refract between 20 to 25 patients each day at Connaught Hospital. On top of his clinical work, as a government employee Koroma attends meetings, completes administrative work and procures lenses and frames.

“There have been times when I feel like it is too much – not only the
challenges in the regions but also in the capital where I work,” he shared.
“Sometimes I wonder, ‘How long am I going to continue to do this work?’ I need people to come on board to join me in the workforce,” Koroma shared.
He initially received training in refraction and spectacle dispensing from Vision Action. Koroma then travelled to Gambia for further study, before completing his five-year degree at Mzuzu University in Malawi.
“When I was studying, many of my colleagues and friends would tell me that I should sit back, work abroad and make a lot of money. I
would say ‘No, I need to give back to my people’,” Koroma shared. He would like to see an optometry course established within Sierra Leone so future optometrists would not need to travel out of the country for their education like he did. Out of the 16 districts within Sierra Leone, five do not have eye care provision.
“In terms of refractive error, we have not scratched the surface yet in Sierra Leone. There will be a small child who is not doing well in school –not because of their learning ability –but because they can’t see,” he said. Koroma shared with OT that his version of success is not about making money.
He emphasised: “I believe in giving to people – my time and my resources. Each day, I come to work, I examine patients and help that person to see. That person is happy when they leave. That is success.”
Selina Powell OT features editor. Get in touch by email: selinapowell@optometry.co.uk“ There are people going needlessly blind
Willie Koroma















Perhaps fittingly, for an edition themed around failure, not everything went to plan during the October/November Optometry Today (OT) photo shoot.
Manoeuvring backdrops into compact spaces required some creative thinking, while optometrist Deepak Oberai shared that the spectacle of a photo shoot outside his Albert Road Opticians practice in Wilmslow “almost caused a small traffic jam.”



“There were lots of curious looks,” Oberai observed.

Oberai’s passion for eyewear (his email signature is ‘Saving the world from mediocre glasses’) was reflected in the fact that he brought three pairs of frames to provide variety within the shoot, alongside two dress shirts. “The photoshoot was a lot of fun. There were more outfit changes than expected but the photographer was excellent to work with,” he said.
Optometrist Stephanie Lipsey-Liu was accompanied by her two dogs for part of the photo shoot at Charles Lea Opticians in Mapperley.
“They were very excited to be in a new place with new people and would barely even sit still,” she shared.
After some initial challenges setting up within a narrow practice, Lipsey-Liu shared that the photo shoot went smoothly.
She said: “The photographer was so nice and instantly put me at ease.
Optometrists Stephanie Lipsey-Liu, Deepak Oberai
Photographer Mark Newton
Art director Grant Pearce








 The practice’s waiting room chair was perfect for the OT photo shoot
The practice’s waiting room chair was perfect for the OT photo shoot
“It is still like when I was a kid – I can’t believe it’s actually my practice,” Stephanie Lipsey-Liu reflected in an interview with OTStephanie Lipsey-Liu with her dogs Daisy, on the left, and Buddy

HOW I GOT HERE
Independent prescribing optometrist, Josie Evans, explains how the ‘narrow door’ of optometry has opened up a wealth of career possibilities

I was thinking about doing medicine for a long time, but I didn’t want to do surgery. I had family members who were optometrists, and they loved their careers and were passionate about them, so it highlighted what a great profession it was. It was last minute, before we had to submit our final choices, that I chose optometry instead.
I went to the University of Manchester, which was the best experience. The supervisors were really hands-on, and wanted to get the best out of us as individuals. They were really engaging, which made us want to do even better for them. I still speak to some of the supervisors today. If I see them at conferences, I run over and say hi. For them, we’re just one of many students, but for us, they’re the people who inspired us to get through the degree.
When I started looking for a pre-reg placement, I emailed a dozen independent practices in or around London, but I didn’t hear back from any of them. I was speaking to somebody at an AOP meeting in my capacity as a student rep, saying how hard I was finding it. They put me in touch with Gordon Ilett, who was director of Linklater Warren at the time. That’s how I got an interview. It’s all down to the AOP that I found a pre-reg placement.
I have stayed at Linklater Warren ever since. This summer, I had been there for six years. It has gone really quickly, but then when I look back on my pre-reg it feels like a lifetime ago.
During lockdown, I was working in practice with one colleague. We had so many emergency patients. We could diagnose them, but I had to refer them to a different practice or the hospital for management. I felt like if we were in that scenario again, I would want to do more.
I started teaching at the end of 2020, as a visiting clinical tutor at City, University of London. Through City, I met Giovanni Montesano, a research fellow with the Crabb Lab. I started working as his research assistant, and we also co-led a separate project. The research looked at structural perimetry, using optical coherence tomography data to determine the starting points of the visual field test, aiming to make it quicker and more accurate. We presented at the Imaging and Perimetry Society, and won an award. That was a monumental moment, because I’d never presented my own work before. With optometry, once you go in one door it opens others. It’s nice to say yes to any opportunity. You never know where it will lead.
I did my independent prescribing (IP) course at the University of Hertfordshire. We would bring examples and ask experienced IP practitioners how they would manage them. The course was fantastic for a general understanding of how the body works. I passed in March 2022.
I started working at Moorfields Eye Hospital two days a week in September 2022, in glaucoma, cataracts, paediatrics, and low vision clinics. Starting a new job is daunting, but I settled in easily.
NAME: Josie Evans
ROLE: Independent prescribing optometrist at Linklater Warren LOCATION: London
It is nice to delve deeper into how I can manage a patient. When I started at Moorfields I was recently IP-qualified. It is nice that I can get lots of experience prescribing in the hospital, as part of a team.
Since January 2021 I have also been a member of Johnson & Johnson Vision’s (JJV) Junior Faculty. I mainly teach virtual classes for undergraduate and pre-reg optometrists, and facilitate peer reviews and discussion workshops for qualified optometrists.
I’ve been thinking about a PhD for a long time, but I’m not sure what I would give up to do it. Another avenue is to consider having my own practice. But I’m quite happy at the moment, so I’m just going to learn as much as I can, particularly from the hospital. In a couple of years, I’ll probably think about making a more permanent mark in either direction.
People can think of optometry as limiting. But it’s a narrow door, and as soon as you go through, the room opens up and it’s huge. You realise it’s full of possibilities.
I applied for a few hospital jobs before I started at Moorfields, but I think it worked out for the best. It allowed me to do IP first, and to take up more responsibility with JJV. So, I would say no regrets.
Many times, I’ve gone home and worried about something that I could have easily checked with a colleague. That’s general advice I wish I had had sooner: if in doubt, ask. It’s better that you go home and sleep a full night than wake up worrying. That’s the only thing I wish I had known earlier. Other than that, everything has happened for the right reasons. I’m a firm believer of that.
I“With optometry, once you go in one door it opens others”
Sheffield-based optometrist, Usman Farooq, explains how locuming has allowed for flexibility when visiting his home city of Edinburgh

Before I started locuming... I was in Edinburgh, working in the practice where I had completed my pre-reg placement. I had a long history with them. It was a good relationship for both parties. Eventually, my family and I decided to come to Sheffield. From there, I linked up with a friend from university and started working as a resident optometrist in a local practice. I did that for a year, and then we both decided to leave and dip our toes into the world of locuming.
He became a locum before I did. Having somebody who had proven that it could be done and hadn’t gone back was a big factor.
I made the decision to become a locum because... Of the flexibility in where I’d be able to work. I’m from Edinburgh, and it became a situation where all my annual leave was taken up going home to visit family.
Locuming allows me to pick up shifts in Edinburgh, so I can go there and continue working, and the days I want to take off I can do something else. The ability to not be locked down in a singular location was the main factor.
When I started as a locum, I wish I had known… That I could give it time, and to be patient, because the right practices and opportunities would appear.
In the beginning, when you look at your diary and you see that it’s empty, that can be stressful. You’ve lost that regular nine-to-five, and the regularity that on the 27th your pay cheque comes in and you don’t have to worry about it. That made me a bit nervous.
I’ve got friends who are locums, and everybody was saying it was going to be fine, but I didn’t believe them. I just had to go through it and learn for myself that things were going to be okay.
On my first day of locuming... I felt very excited. It was a bit daunting going into a new practice, and I didn’t want to inconvenience anybody. It was a big place, and very busy. Everybody had something to do, so I didn’t want to be asking,
‘What do I do? How do log in? What are the referral guidelines?’ But those questions do have to be asked every time. Over time, you understand that.
My biggest locum challenge is… The days I’m not working, even if it’s a holiday or a sick day. I didn’t take any sick days until I became a locum. Luckily, I just didn’t get ill. Understanding that one of the cons of being a locum is that these are issues that you will have to face is something I’m still getting to grips with. Being okay taking an extra day off here and there without pay, and knowing that if you need to take a sick day, that is what you need to do – that’s still a challenge I’m navigating.
NAME: Usman Farooq
LOCUM FOR:
One year LOCATION: Sheffield
Practices can make life easier for locums by… Prioritising communication. I understand that that can be hard when there’s a lot going on and you have your practice to run. The last thing you want to be doing is worrying about the locum. But communication is key, especially if changes happen in the diary, or you’re swapping over a clinic. Surprises aren’t nice. If practices could minimise them, that would be better.
As a locum, I’ve adapted my days by… Knowing that every day is about first impressions. As a resident, you might be more relaxed, because you’ve built those relationships with people.
I don’t need to adapt much of my testing routine. It’s more about going in with a big smile, because this is probably the first time a lot of the staff are seeing me, even if I know the director or another optometrist there already. I’ve worked in quite a few places, and it is always a case of good first impressions.
My advice for new locums is...
Take it easy. It’s a long road. Not locuming itself, but the career path. Don’t be in a rush to do everything. Locuming is not for everybody. I have plenty of friends who are still resident optometrists, and they like residency, and that’s absolutely fine. Don’t feel like you have to do this. But if you do, don’t panic. Take your time. It’s not a war zone. You will
I“Surprises aren’t nice. If practices could minimise them, that would be better”
Every edition, OT poses a series of questions to a hospital optometrist. This time: SpaMedica’s regional optometrist lead for South and West Yorkshire, Sadiya Mulla

Could you describe working as a hospital optometrist in one sentence?
Rewarding, challenging, interesting and amazing – often all at the same time.
How long have you worked as a hospital optometrist?
Four years. Sometimes it feels longer than that, because of the opportunities and depth of experience I’ve had in a short space of time.
Why did you decide to become a hospital optometrist?
I’d considered being a hospital optometrist while I was studying at the University of Bradford. Later, whilst working as a resident optometrist in a community practice, I dealt with a patient who had a significant abnormality pressing on her spine, which affected the signalling of the optic nerve. I saw how important the role of the optometrist was in triaging our clinical findings. This life-saving situation was the point where I knew I wanted to become a hospital optometrist.
What is the biggest challenge facing hospital optometry currently?
In an ageing population, we’re seeing increasing numbers of patients with conditions such as glaucoma and macular degeneration, who need ongoing monitoring and treatment. We need to continue upskilling, ensuring that greater numbers of hospital and community optometrists can provide care in these areas –giving patients the right care at the right time.
What is your biggest success in the past three years?
Being promoted from hospital optometrist to regional optometrist lead. Not only am I looking after a fabulous team, I’m also involved with some interesting projects, such as our first glaucoma monitoring service at SpaMedica, which recently launched in Yorkshire.
What is the most surprising case you have seen in the hospital setting?
I had a patient with a limited fundal view, due to a dense cataract. He came back for a follow
NAME: Sadiya Mulla
ROLE: Regional optometrist lead at SpaMedica LOCATION: Wakefield
up, with limited vision, post-surgery. He had a choroidal melanoma filling his macula region. Luckily, his eye was saved from enucleation.
What would you say to optometrists working on the High Street about working in a hospital? It is the most rewarding job. Regularly seeing the reaction of patients, when you have changed their eyesight for the better and given them their independence back, makes coming to work so much more worthwhile.
As pandemic restrictions started to ease, it felt like we were making a big difference, helping patients access the care they needed and working to reduce waiting times. We only closed our eye hospitals for a short time, and then our teams worked tirelessly when returning to make sure patients continued to get the care they needed. We see patient satisfaction every day, and receive lots of positive feedback, which is a great part of this job. But that period sticks out for me. We were working exceptionally hard for our patients, when they were facing such stress and uncertainty.
“I saw how important the role of optometrist was in triaging our clinical findings”



















Hayley Smith explains why undertaking her pre-reg at the independent practice she had worked at since starting her degree was the best fit for her

The pre-registration year is mentioned on the very first day of university, but is a year that always seems so far in the future.
When the time comes to start looking for a pre-reg placement, it feels surreal. During my final year studying optometry, I couldn’t believe that soon I would be leaving the comfort of university, with all my friends, lecturers and supervisors beside me, to work in the big bad world. Although I was feeling apprehensive, if I learned anything at university it was how to navigate nerve-wracking times – which this certainly was.
Choosing a pre-reg setting
I studied at Glasgow Caledonian University, which was great at informing us of the opportunities offered by multiples, including presentations about the process of applying and the locations offering pre-reg placements.
I had been working Saturdays at an independent practice called Peter Ivins Eye Care since my first year of university. However, the

NAME: Hayley Smith
ROLE: Pre-registration optometrist at Peter Ivins Eye Care LOCATION: Bearsden
likelihood of being able to complete my pre-reg there was low due to the number of testing rooms available.
After applying for placements in both multiple and independent practices, I attended an interview and was subsequently offered a place at a multiple. I was keen to take this, butwhen Peter Ivins Eye Care suggested that it may be possible to stay on to do my pre-reg at the practice, I realised how keen I was to continue to work in a setting I had grown so fond of. There was no doubt in my mind that this would be the best fit for me.
I am delighted to be completing my prereg at this practice, after seeing how much staff prioritise patient care. They also have specialised clinics, including dry eye, myopia management, and visual stress, which have demonstrated how I could specialise. I plan to expand my clinical skills to enable me to take part in these clinics myself eventually. It makes me feel at ease, knowing I will be working alongside a great team who are happy to help and share their wisdom.
The practice has been great in helping me prepare, allowing me to observe sight tests, running me through their system, and making me feel comfortable by welcoming any questions. They have also set up hospital placements, lab visits and courses to assist my learning throughout the year. Staff are making my transition to pre-reg as smooth as possible. The faith they have in me has built my confidence. I am thrilled to know I have a good support network.
Preparing for the year, I am feeling emotions ranging from excitement to nervousness. I am eager to use my skills to make a difference to patients, and excited to have more independence than I had at university. With that comes nerves, but I have no doubt that others are feeling the same way. It will be a challenging yet rewarding year, and I cannot wait to see what is in store.
ORAN SAYS
The process of finding a pre-reg placement was... made easier thanks to communication. University provided support for assessment days and interviews, and we were also asked our preferences, to best match candidates with practices.
Ahead of starting my pre-reg, I feel… excited to put my skills into action, enabling me to have a positive impact on my patients.
I chose to complete my pre-reg at Specsavers because… I was already working as an optical assistant, so had built a relationship with practice colleagues. It is a friendly environment, and everyone is on hand for support.
Oran O’Connor is a pre-registration optometrist at Specsavers Newtownards






05:30
When I wake up, I have a lot of things whizzing in my head. Depending on how energetic I feel, I go for a walk or a run – something to start my day and clear my head.
06:30
For breakfast I’ll have granola or a smoothie, or porridge with fruit. I catch up on the news and on football transfer gossip. We’re obsessed with sport in my family.
07:15
I love listening to podcasts in the car. They vary between optometry, business, and sport. During the summer, I enjoyed listening to the cricket. The Ashes were great.
07:45
Owner of Lunettes Opticians, Tushar Majithia, walks OT through a working day that’s punctuated by sports updates and family time

NAME: Tushar Majithia
We’re relocating our Grantham practice, so I check in with the contractors to see how things are progressing, which takes 15 or 20 minutes.
08:30
When I get into the practice I have a cup of tea, catch-up with the staff, reply to messages and emails, and look at what’s ahead in the diary: what appointments I’ve got, which patients, and if there are any problems that might need to be considered.
10:00
Day-to-day, I do the testing. We have quite a mix of appointments: eye tests, contact lens work, low vision, and enhanced services work. No day is the same, which makes it interesting.
12:30
I grab a jacket potato, a salad, or a sandwich. It’s nice to have a bit of fresh air, so I go out for a quick walk.
There is a lot of diagnostic equipment that we would love to have. When we invest in technology and new equipment, we want it to be sustainable. It has to be viable to bring into the business. We’d like to get widefield imaging, something like a Daytona. Also, myopia management devices.
I will then answer emails and phone calls, catching up on the news and sport at the same time.
15:00
I don’t tend to get involved a lot with the day-to-day running of the business. The staff are all quite motivated and know their roles. If there is a quiet patch in the diary, it’s nice for them to have a chat and a gossip. That’s good for team building, and makes for a more enjoyable working environment.
17:00
OWNER OF: Lunettes Opticians LOCATION: Lincolnshire
We usually work until 5pm. On a Monday or Tuesday, I’ll play tennis after work. A couple of times a week I’ll go to the gym or for a swim, and meet the family there. In the summer, it’s nice to play nine holes of golf with some friends, and then have a drink afterwards.
19:00
We tend to knock up dinner quite quickly: pasta, stir fry, chilli, or fajitas. If I do go to the gym or we go for a swim, we can come straight home and have that.
19:30
In the evenings, I relax with the family. We quite often watch a series on Netflix, or food or travel programmes. We’ve started watching Break Point, a Netflix series about tennis. We’ve also been watching Hijack on Apple TV, with Idris Elba. Also, things like Ted Lasso – lighthearted shows that are enjoyable to watch as a family.
-
Read about Tushar’s day in more detail on the OT website: www.optometry.co.uk/adayinthelife
It would be nice to have technology that integrates all the bits of equipment, such as the topographer, the optical coherence tomography and the visual fields, and brings all the data seamlessly into the patient record. If money was no object, we would get a Myopia Master. On luxury items, it would be nice to have amazing pieces of art within the practice, so patients can have a look around while they’re waiting for their appointments.
“IT’S BETTER TO EMPOWER THE STAFF TO SOLVE THEIR OWN PROBLEMS”
OT presents a clinical scenario to three of our resident IP optometrists. Here, a woman presents with a potential allergic reaction to false eyelashes ahead of her daughter’s wedding
The scenario:
A woman comes in with sore eyes, red and swollen eyelids, mild photophobia and watering. She had some false lashes put on at a beauty salon yesterday. Two hours later, her eyelids became hot, tingly and itchy. Her daughter’s wedding is tomorrow and she’s desperate for some help. What can you do?

OT’s panel says...
Kevin Wallace (KW): This is likely an allergic reaction to the adhesive used. The most important thing is to remove the allergen: in this case, the lashes and their adhesive.
Although it isn’t clear at the moment that this is actually an eye problem, it is clearly affecting the adnexa so is reasonable for an optometrist with appropriate experience to treat.
Once you remove the allergen, the usual treatment of regular lubrication and a cool compress will give her some relief and reduce
the signs in most cases. The added wrinkle in this case is the fact that the patient has a wedding tomorrow and will be concerned about cosmesis.
I think it is unlikely her symptoms would resolve in time for the wedding with any treatment, but a short course of ‘non-penetrating steroid’ may improve the signs and symptoms. There is also a conversation to be had about whether she should wear any eye make-up tomorrow, as well as the risk of a short course of steroids and whether they are necessary.
Ankur Trivedi: I would ask whether she had had false lashes before, either with the same or no reaction, and whether patch testing was done prior to treatment, to rule out any chance of reaction. There is a likelihood that this is an allergic reaction to the lash glue, or to some other element that

OCCUPATION:
AOP clinical adviser

YEARS IP-QUALIFIED: 11 years
OCCUPATION:
Clinical multimedia editor
YEARS IP-QUALIFIED: Five years

OCCUPATION:
AOP IP Councillor
YEARS IP-QUALIFIED: Nine years

was used for the treatment. The first thing would be to remove the lashes and glue to remove the allergen or trigger. Given the context, I imagine this would not be welcomed, so I would want to prescribe steroids – ideally non-penetrating, and available in a preservative-free version.
Ceri Smith-Jaynes (CSJ): This is a real case from practice. The patient had had the eyelash extension treatment before, with no adverse reaction.

Something in the glue has probably caused the reaction. It has been suggested that formaldehyde in lash extension glue can be emitted from the glue a few hours after application and can be volatile, depending on temperature and humidity. This is a potential cause of the reaction in the skin.


This patient is complaining of photophobia, so I’m going to need a good look at her cornea, with fluorescein, as there is likely to be keratoconjunctivitis too. The volatile compound can dissolve in the tear film and cause ocular surface damage. This patient had a small infiltrate on one cornea, along with bilateral inferior staining and bulbar and palpebral hyperaemia. There was a bit of yellowy discharge as well as glue residue on the lashes.
KW: It’s important to examine the rest of the eye – particularly using fluorescein to assess the cornea. I always check what the patient can see before we start too – clearly reduced acuity is an important sign in any eye problem and a pinhole is very useful to differentiate ametropia from a pathological reason.


CSJ: The most appropriate College Clinical Management Guideline to apply here is Conjunctivitis medicamentosa (also Dermatoconjunctivitis medicamentosa), described as “chemical irritation of ocular and/or adnexal tissues by a topically applied drug, contact lens care product or cosmetic, or by environmental or occupational substances.”


Treatment guidance includes withdrawal of the offending


medication or preservative and cold compress (symptomatic relief). Eyelash glue requires an oil to dissolve, so you’ll need an oil-based cleanser, eye make-up remover, olive oil, or Vaseline. I’d try warm water first, though. The lids are sore and inflamed, so I’d get a cool gel pack on as soon as the lashes are off.
I’d advise copious ocular lubricants, which will be soothing if you refrigerate them. I’d prefer to go preservative-free for any treatment in this case – dexamethasone or prednisolone steroid drops are available in unit dose and will help with inflammation.

It’s important to measure visual acuity. I don’t think I want to hit this lady with Goldmann tonometry if she’s struggling to open her eyes, but I’ll check IOPs when she returns for follow-up. I’d like a baseline





IOP reading because of the steroid treatment. I don’t anticipate her needing the steroid for more than a week or so. I also considered the College guidance for chemical trauma. My first thought was allergy, but is it actually a chemical burn? Although the reaction is delayed, is that because the glue warmed up to skin temperature and released volatile compounds that damaged the eye and dissolved into the tears, rather than a real hypersensitivity response? If cases like this present, should we be irrigating?
In my area, anyone who phones their GP and uses the word ‘eye’ is signposted to CUES. Even if the examination results in palliation and referral, the referral will be more effectively triaged with a good quality letter detailing the findings.
Sometimes, I’ll phone and the ophthalmologist will ask me to start a treatment, then they will follow up. This is great service from the patient’s point of view.

“I’d prefer to go preservative-free for any treatment in this case”
Ceri Smith-Jaynes
The purpose of SharkLink
Nichola Mason (NM): We’re a group of seven partners with a variety of practice types, skill sets and time working within the group, representing Hakim Group partners, who are known as ‘Sharks.’ Our role is to ensure HQ remains aligned with the group’s practices, maintaining the culture as we grow.
Neil Hilton (NH): The main thing is to ensure there’s no disconnect between HQ and practices. We’re one big team, and our objective is to maintain that culture and family feel, whether we’re 600 practices or six. That was the focus of SharkLink, from when we first began.
NM: Hakim HQ was looking at opportunities to provide better terms with alternative banks. Everything we do is trialled with a small number of practices before it’s rolled out to the group. In this instance, the trial showed a few bumps. Being able to feed that back through SharkLink meant this was addressed. The process is there to mitigate any challenges.
NH: We started from a really small number of practices, and we’ve scaled quickly. What was suitable five or six years ago could probably now be better. The culture is always to innovate and reflect and try and better ourselves.
SharkLink is there to support and sense check HQ. We’re privileged that we can get involved in these conversations. Recently, we’ve taken the auditing and governance platform back and made a few tweaks. It’s a question of, ‘how can we improve this and make it better for a group of 400+ practices as we grow, rather than a group of 100?’ You learn from your setbacks. It’s a learning experience, which is cool.
NM: It works both ways. If there’s something in practice that HQ think we could do better, we’re always willing to listen, and they’re equally willing if they’re doing something we think isn’t right in practice. They’re very quick to adapt and change if needed.

NM: I work with lots of the new Sharks. We cover lots of things that they have never experienced,
because they’ve been a dispensing optician, optometrist or practice manager, and suddenly they’re a business owner.




During onboarding, we included a finance session and talked about some of the fundamentals. These sessions were really well received, and made us question if other longer standing partners within the group may also have finance areas they would benefit from revisiting: VAT or corporation tax, for example, which might sound quite basic, but when you have spent your career patientfacing, its an area that gets overlooked. From these conversations we saw an opportunity for Sharklink to try and help.
At the roadshow this year, we did a session with Richard Woolley, financial controller at HQ, and SharlinkLink member Gavin Rebello. The feedback from Sharks was brilliant. One said, ‘I have been too afraid to ask that question about tax. I thought I should have known the answer.’ Some of the new owners don’t want to ask questions on subject areas that they might be unsure of. That was unexpected, but through listening we could understand and put a solution in place.
NH: As SharkLink, we’re trying to be present at every event that we do, to give people the confidence to chat to us if there are any issues. We’re becoming more outward facing. That’s the next evolution of SharkLink.
NM: In 2024 we want to be able to connect more easily with other partners. We would like to set up more local connections, so they’ve got more opportunities to connect, discuss, and share with us and our fellow Sharks.

NH: We are planning for 2024 and looking at reaching out to the brilliant partners across the UK. Every time we get together, we’re seeing how we can connect with people better. It’s top of our agenda.
0
NAME: Neil Hilton
NAME: Nichola Mason

ROLE: SharkLink treasurer and partner at four Hakim Group independent practices






LOCATION: Cambridgeshire

“The culture is always to innovate and reflect and try and better ourselves”
Neil Hilton, SharkLink chair and partner at six Hakim Group independent practices
Registration has opened for the largest optical event in the UK.
The 2024 show will be held at ExCeL London from 24–26 February.

In preparation for the event, OT sought out the latest in equipment and technology.
Celsa Vazquez, commercial director for 100% Optical, shared how the footprint of manufacturers and suppliers has changed over the past 10 years of the show: “The presence of equipment suppliers and manufacturers has gone from strength to strength at 100% Optical.”
“When we launched back in 2014, we had the support of Zeiss. Gradually over the years we have grown this side of the show and are now proud to boast a full spectrum of equipment suppliers and manufacturers including
world leaders Zeiss, Topcon, Optos, Birmingham Optical, Mainline Instruments, Spectrum Ophthalmics, RetinAI, Lumenis and many more,” she added.

The area of the exhibition dedicated to equipment has become a hub for the latest in technology, and Vazquez described it as a “focal point for launches and live demos.”
This makes for an exciting opportunity, with the organisers finding that 60% of visitors attend the show with the intention of making purchasing decisions.
Topcon will return to the show, bringing its top solutions including Myah for myopia management, and Eye-light for dry eye.
A spokesperson for the manufacturer suggested that, alongside this, there will also be “optical coherence tomography (OCT), new lasers, and other devices yet to be launched.”
Supplier, BIB Ophthalmic Instruments will be bringing its suite of devices. Managing director, Tim Baker, said: “Delegates can expect to see how the latest technology can benefit their clinical offering whilst providing a return on investment.”
After making a splash at the 2023 show, Optopol’s Revo FC 130 will be on display, and
OT hears what to expect from equipment manufacturers and suppliers at 100% Optical and how the show provides a space for growth
SK-MED’s new high specification Digital LED Slit Lamp with automated Dry Eye Analyser will also be on the stand.
The new Zulu 3 from Medinstrus, a threetable rotary combi unit, will be a conversationstarter, along with a new range of refraction and diagnostic equipment from Visionix.
Birmingham Optical will showcase products from across its divisions of lens edging, optometry and ophthalmology, including the highly anticipated Nidek fully-assisted refraction system for TS-610.
“We will also be heralding our new myopia management offering in the form of the Nidek AI-Scan, along with the latest Retina scan Duo 2 OCT,” the company shared.
Spectrum Ophthalmics will exhibit its range of dry eye solutions, with the OptiClear IPL taking centre stage. The company suggested the treatment option “creates a mutually beneficial lasting relationship between the patient and optometrist through a specific course of treatments and service-led plans that address eye care issues and ongoing good eye care and health.”
Following a new distribution partnership with Oculus Optikgeräte, Mainline Instruments will introduce Oculus devices to the show.
Zeiss is proud to have supported 100% Optical since the first event in 2014. Over the years Zeiss has launched multiple new products at the show, hosted numerous educational sessions and met with countless customers – both old and new.
With a fun and fresh approach to the visitor experience, 100% Optical is now a key date in the optometry calendar and we look forward to being part of the expansion into ophthalmology in 2024.
The programme for education and presentations at 100% Optical is under construction, organised by the AOP, as education partner for the show.
Dr Ian Beasley, AOP head of education and OT clinical editor, said: “As we enter the final year of the new continuing professional development (CPD) cycle, we will be providing more than 1000 spaces in peer review sessions, as well as covering the domains for all practitioner types.”
“100% Optical provides a supportive environment for delegates to learn alongside practitioners working across a range of clinical settings to help identify areas where they need to consolidate and expand their knowledge and fulfil their professional development needs,” he added.
Peer review is a core component of the threeday CPD programme.
A spokesperson told OT: “Join us at this grand event to experience firsthand the latest innovations in eye care technology and discover how Mainline Instruments is shaping the future of optical solutions for professionals across the board.”
Rebecca Seymour, marketing manager for HSUK, said: “We will be running our exciting Eyesi Slit Lamp simulator competition on our stand, offering delegates the opportunity to test their slit lamp skills and win a daily prize.”
The Haag-Streit Academy is also sponsoring the 100% Ophthalmology Education Hub on 25 February. Seymour shared that speakers will deliver lectures on topics including myopia management and slit lamp simulation, using HSUK equipment.
Vazquez said: “The education programme is a space for optical professionals from all specialisms to come together to evolve their knowledge. Across 11 different theatres and workshops, visitors will hear from those offering learning and practice training.”
“Whatever stage of your optical career you are at, the event is a must-attend, with free registration now live,” she concluded.
100% Optical was recently recognised as ‘Best Brand Collaboration’ at the Exhibition News Indy Awards. The partnership between the AOP and Media 10, organisers of the event, has been in place since July 2013.
Have you been attending 100% Optical since 2014?
Get in touch with OT to share your stories from past shows at newsdesk@optometry.co.uk
“ Whatever stage of your optical career you are at, the event is a must-attend”
Celsa Vazquez, commercial director for 100% Optical
Registerfor the free contactlenseducationalplatform whichoffers engaging,innovative, and up to the minutetrainingfor all. Whetheryou are a student, retail associate,store manageror seasonedopticalprofessional,there will be somethingthere to interest you.

Featuresto explore:
• Check out the News section for details regarding live contact lens CPD events






• Listen to latest research and scientific information from leading optical experts

• Support your practice staff with their learning
• Gain top tips for success from other optical professionals and share your own
• Find tools and information to support the growth of your practice.


• Contact lens CPD modules available and updated regularly.




• Build your personalised learning portfolio complete with downloadable and printable certificates.


As part of the requirements, qualifications must integrate a minimum of 90 hours “learning and experience in practice”, and trainees must have identified a designated prescribing practitioner as a supervisor for their placement.
Optometry education in the UK is changing, as universities redesign courses to meet the new education training requirements (ETR) set out by the General Optical Council (GOC) in 2022, bringing change at both undergraduate and postgraduate levels.
Explaining the new independent prescribing (IP) requirements, Samara Morgan, head of education development at the GOC, shared: “The changes for our qualifications in additional supply, supplementary prescribing, and independent prescribing, mean that trainees will acquire a single qualification approved by the GOC, leading to specialist entry to the GOC register in the relevant category, rather than the two approved qualifications gained either sequentially or simultaneously at present.”
First across the line Aston University’s postgraduate IP course was the first to be noted by the GOC as meeting the new requirements, with the initial cohort joining this October. Dr Preeti Bhogal-Bhamra, director of optometry postgraduate taught programmes at Aston University, told OT: “The main difference is that, in the past, the course has been based on the theoretical knowledge of prescribing and pharmacology.
“What we are finding now, to our delight, is that there is more on the actual prescribing. There is a lot of consideration given to ethics in the learning outcomes now, as well as safe prescribing and taking responsibility for your role,” she said.

Replacing the therapeutic common final assessment, theory will still be assessed throughout the course, but more weighting will be attributed to the actual placement itself.
“We found that the clinical placement was where everybody felt they learned the most,” BhogalBhamra said.
“We wanted to place more emphasis on the learning journey during the clinical placement. We think that will help students as they are working through their course,” she added
Students will be responsible for sourcing their clinical placements, but now that this is integrated into the course, the university will be able to provide a greater level of support and has sought to forge links with local trusts in preparation.
Dr Michelle Hennelly, head of optometry and visual science at City, University of London, shared that many higher education institutions are considering how best to integrate the placement into the IP qualification. “At City, we will be combining theory with clinical skills and signposting
In the third part of a series on the IP workforce, OT explores what changes in education and training requirements have meant for pathways into independent prescribing, now, and looking ahead
key elements in practical workshops prior to going into the placement. This will give students the most opportunity to gain relevant experience,” she said.
Hennelly is part of the Sector Partnership for Optical Knowledge and Education (SPOKE), which was commissioned in early 2023 to form a Knowledge Hub, facilitating conversations in the sector in preparation to meet the requirements for the new IP courses.
SPOKE has established a list of learning indicators associated with the Outcomes for Approved Qualifications for independent prescribing.
“Once published, this will enable higher educational institutions to develop the new IP programme,” Hennelly said. “The main purpose of SPOKE is to support the successful implementation of the new GOC requirements.”
Considering the plans for City’s IP course, Hennelly suggested: “Finding a placement will be much easier in the integrated programme, because we will be working with partners to broker placements. We will support students in getting the placement in the first instance, and then we will enhance the learning during their placement experience.”
This added support will help combining theory with practice, by considering different types of eye disease and supporting students with further development of eye disease management skills, she continued.
Cardiff University has also been looking at its IP programme, and how the course can support optometrists on their clinical placement.
Angela Whitaker, senior lecturer and IP programme director for Cardiff University, said: “It’s an opportunity to help students make the most of the placement for their own individual clinical context, for what their ambitions are, and to tailor that placement experience to help them develop into the optometrist they want to be.”
Cardiff University plans to expand its teach and treat clinics in order to support the provision of placements. Successful teach and treat clinics have been running for two years for glaucoma, medical retina and oculoplastics, while an independent prescribing optometry service (IPOS) has recently launched at the university, creating additional opportunities for IP placement provision.
However, placement capacity remains a key question for providers. Whitaker acknowledged: “For me, the single biggest issue is placement capacity; we need high quality clinical experience that is relevant and meaningful, to help optometrists develop their skills and confidence.”
Bhogal-Bhamra also acknowledged: “With the number of applicants that come through for IP, the level of interest and the demand, I do think we will still face those challenges.”
The GOC’s move to allow IP optometrists to act as a designated prescribing practitioner (DPP) could help to ease some of the pressure around placement capacity, broadening the scope of who can supervise. However, Dr Peter Hampson, clinical and professional director for the AOP, has cautioned that the requirements the DPP must meet may limit those who could supervise, sharing: “Whilst there are some practices and practitioners with the correct case mix, unfortunately I don’t think there are that many.”

Optometrist, Ankur Trivedi, the AOP’s Councillor for IP optometrists, said that placements have been a “definite barrier to gaining the IP qualification.”
Trivedi, who qualified in IP in 2014, self-funded his placement at Bristol Eye Hospital, but said: “I was really lucky, in that I knew the right people to signpost me to that pathway.”
In Gloucestershire, the Trust historically has not been able to provide a pathway for external IP candidates, Trivedi suggested, recognising that to be able to offer such a provision for any hospital setting could feel like a lot of “red tape” for both the IP student and the hosting hospital.
Work has been ongoing with the local hospital trust, with input from the local optical committee, to establish placements for a cohort of trainees with Trivedi explaining: “A couple of colleagues are now going to be the first in Gloucestershire to do their IP placements locally.”
Samara Morgan, GOC head of education development

This is something that, following discussion with Trust colleagues, will lay the foundations or a clear pathway for future candidates looking to do their placement in their local hospital.
The new requirements allow for greater flexibility in how qualifications are provided. One particular change has removed the requirement for an optometrist to have been qualified for two years before taking on prescribing qualifications.
Morgan, from the GOC, told OT that providers may choose to integrate the Additional Supply, Supplementary Prescribing, or IP qualification within their undergraduate optometry level 7 programmes, “resulting in the student acquiring two qualifications.”
The qualifications will remain separate, ensuring qualified optometrists will continue to be able to access standalone training, Morgan noted.
Hennelly shared that the advent of the MOptom brought up the question of including prescribing as part of the Master’s level of learning.
“One of the issues that we felt, was the consideration around experience, and would you have enough clinical experience in a four-year degree to exit the award as a prescriber?” she told OT. “I think our sense was ‘no.’”
universities to engage with stakeholders and develop the clinical placement model.
Hampson noted the issues around placement provision: “The challenge around clinical placements for those outside of Scotland and potentially Wales remains, and these are likely to be hard to find. I hope that we don’t find ourselves in a situation where we have built expectations amongst new entrants to the profession that ultimately we struggle to meet.”
Gaining experience is crucial, and a key challenge, he continued: “Ensuring graduates with IP not only have the qualifications, but also the correct level of experience to prescribe safely, is a significant challenge.”
As of 17 August, eight optometry qualifications had met the GOC’s new requirements, with providers offering the MOptom from September 2023.

Providers have taken a variety of approaches to addressing prescribing – some incorporating the theory as standard, while others have introduced optional modules for final-year students.
Cardiff University and Ulster University were the first to meet the GOC’s new requirements for undergraduate provision.
1231 independent prescriber registrants
Hennelly pointed to the Master’s programmes in pharmacy, operating as five-year courses, where students graduate with the ability to prescribe, suggesting that the extra year could offer the necessary additional experience.
With the new Wales General Ophthalmic Services (WGOS) contract coming into play alongside the changing requirements for optometry education, Whitaker shared: “In essence, the core level is higher than the current level, or needs to be. So, our training at undergraduate, postgraduate IP, and other courses we run, has been looking ahead at what optometrists in Wales are going to need – not just now, but in the future, because there will continue to be ongoing development in the role of the optometrist, which is to be welcomed.”
as of 31 March 2022
Source: GOC
Graduates of Cardiff University’s MOptom will have covered the theoretical elements of IP, ready to take on a clinical placement, and will also have had the opportunity to work towards a suite of professional certificates.
Discussions in Scotland seem to be working around this approach, with the Scottish Government working with both Glasgow Caledonian University and the University of the Highlands and Islands as they develop new undergraduate programmes.
A letter from the chief optometric adviser to the community eye care sector suggested this could incorporate independent prescribing as part of a five-year Master’s degree.
NHS Education for Scotland is supporting the
Whitaker said: “Over time, we would like to embed the placement in the undergraduate course, but we don’t have the capacity at the moment.”
Dr Julie McClelland, senior lecturer in optometry at Ulster University, shared with OT: “We are fortunate in that our MOptom programme has been running successfully for a number of years, which has helped to prepare the staff for this shift in course delivery.”
According to module guidance shared on Ulster University’s MOptom webpage, in the
final year of the four-year degree, students will have the option to undertake a module in Ocular therapeutics and prescribing
The optometry school suggests that successful completion of the module, as part of the MOptom programme, could set students on a path to apply to join the specialist register as an IP optometrist in the future.
Details are in the process of being finalised, but McClelland confirmed: “We consider IP knowledge and skills to be an important part of optometrists’ skillset in future years.”
At City, students in their fourth year will be able to choose a path of learning towards medical retina and glaucoma professional certifications, or to progress their prescribing knowledge – experiencing the theoretical half of the IP programme. Having graduated, students would then need to take one final module and complete a placement to become IP qualified.
Structuring it this way, Hennelly shared, “helps to deliver a sense for the student of where they want to aim to be, and what their commitment and career path is,” and graduates will also have the opportunity to gain experience as a qualified optometrist, before returning to complete the IP qualification.
Hennelly explained that the College of Optometrist’s clinical management guidelines will be embedded much earlier in the MOptom programme. “We’re going to make sure that students are aware of those from year one, and build on that as a resource for learning so that they are much better equipped and familiar with the gold standard or the framework on which IP is structured.”
Pharmacy has seen its own changes in the training of independent prescribers following updated standards from the General Pharmaceutical Council (GPhC) that removed a requirement to have been qualified for two years before undertaking IP training.
Laura Wilson, spokesperson for the Royal Pharmaceutical Society, shared that candidates will instead be
Looking at the changes in education, Trivedi suggested there could be opportunities for a cohort of undergraduates “with a lot of knowledge already from the course and who are still in that learning zone.”
He emphasised the importance of the postgraduate programme, recognising that for some, gaining experience in practice before returning to gain the additional qualification would remain the best route.
Reflecting on the role IP plays in the profession, Trivedi shared: “There’s a misconception sometimes that the IP qualification is just about prescribing. It does give you the skill and the power to prescribe, but it is about the general management of patients as well – knowing when you maybe don’t need to prescribe and can just monitor and discuss with the patient what to expect and any red flags to get in touch about.”
With the changes in education, Morgan told OT: “The new education and training requirements were introduced in response to enhanced optical roles dealing with an increased volume of eye care and provision of specialist services in the community, helping to ease the burden on the NHS.
“Independent prescribing has a role to play, along with many other education and training opportunities and initiatives in eye care.”
IP is not a path that all optometrists see themselves taking and Morgan noted the continuing professional development and training available is “designed to meet different needs.”
She said: “There will continue to be standalone optometry (OP) qualifications available as well as OP/IP integrated, and IP standalone qualifications available for individuals to choose their own pathway.”

OT’s full series exploring the IP workforce can be found at: www.optometry.co.uk/upskillingip
required to ‘demonstrate readiness,’ adding: “Course providers will assess the quality of a candidate’s experience prior to them starting the course, which is also accredited by the GPhC.”
Undergraduate training is also evolving, Wilson shared: “Changes to the initial education and training of undergraduate pharmacists now incorporate the skills, knowledge, and attributes for prescribing, to enable
pharmacists to independently prescribe from the point of registration.”
The first cohort to graduate with IP-ready status will be in 2026.
Increasing the numbers of IP pharmacists will help to improve patient access and reduce pressure, Wilson said: “Our healthcare system is evolving, and we need to change with it to ensure patients still receive world class care in all settings.”





































































In a roundtable discussion, in partnership with SpaMedica, OT asked: how can private providers support optometrists to enhance the patient experience?
Optometrists are increasingly finding that referring patients to private providers for treatment can relieve stress and allow them to be seen more quickly than they would be otherwise.


In hosting a roundtable discussion in partnership with SpaMedica, OT gathered a group of eye care practitioners to discuss this approach – from knowledge-sharing and upskilling through a two-way referral process, to ensuring patients are ready for surgery and the value of staying in communication patient afterwards.
Karen Hunter has been referring to independent NHS service providers since 2015. OT asked what benefits she has found in this approach.
“It opens another avenue for referral, when waiting lists are getting ever-longer, and provides more options for patients,” Hunter explained.
Hunter’s patients often hear on the grapevine about successful operations and ask whether they can be referred to the same provider, she said, emphasising that this route has allowed for greater patient choice.
“To give patients an option is brilliant,” she said. “To open up the referral process hopefully means waiting lists come down, more people can get their surgery, and we can see patients living happier lives – that’s why I started.”
In her time referring patients to NHS service providers, Sarah-Jane Smith has learnt how important it is to be able to pass a high level of information to the practitioner who is performing
the pre-assessment. “I try to make sure it will run smoothly: if they have any access issues, if they’re in a wheelchair, if they’re going to be attending with someone, if they’re hard of hearing, and make sure there’s enough detail in the referral,” Smith said.
Making the provider aware of any underlying pathology and if the patient has certain expectations is also key, she said, because “it allows them to confirm and elaborate on what has already been discussed.”

The patient also has a head start to think about what they’re going to be asked. It is a few bullet points on the key takeaways – anything that might hinder the prognosis and whether I’ve discussed it, giving as much information as possible,” she added.
When considering feedback on referrals for surgery that has not gone ahead, Hunter emphasised that there is a duty of care to a patient who is insistent that they want to have their cataracts removed, even if the hospital decides the operation is not needed.


“It’s hard for the patient to get their head round,” she said. “To a certain extent, it’s a hard conversation to have, because they’re frustrated,

and you can’t do a lot to help. But just try as best you can to explain the problems, and go through the risks of cataract surgery. A lot of patients will accept that there are risks involved, and if their vision is good and they can live with it, a lot will carry on.”
She added: “It’s having those conversations, so they understand and appreciate why we can’t do their surgery. There’s a vision limit and a cut-off for a reason.”
Receiving results post-treatment is important, Smith said: “It allows me to track the patient through the process. I go through what will happen with them, and tell them that I will get a letter and I’ll know when [the surgery] is going to go ahead.”
She added: “When we receive a letter to say that the patient has had the operation, we touch base for a welfare check, which allows us to get them booked in for their post-op check.”
This back-and-forth communication helps patients feel supported throughout the process, Smith said.
OT is interested in hearing how information is shared between professionals who are looking after the same patient – that is, between the hospital and the practice.
Hunter believes that “bridging that gap between the hospital, yourself and the patient is vital.”
If hospitals have not kept the referring optometrist in the loop they can be left on the backfoot when patients ask questions, she said.


The two-way communication is something that all the practitioners find vital to the process.
In terms of SpaMedica’s communication process, Woodhouse emphasised that “for me, it couldn’t be better. We’ve got complete access, and nobody thinks we’re mad for following up and asking questions.”

“TO GIVE PATIENTS AN OPTION IS BRILLIANT”
Community optometrists who refer patients into secondary care play a key role in ensuring they have the best outcomes. So, how can optometrists ensure that the patient’s eyes are ready for treatment? And how do practitioners explain that the health of a patient’s eyes will play a role in their surgery outcomes?
Smith explains that outlining what the referral includes and breaking down the clinical reasons for certain things – for example, why a patient might need to use eye drops – is helpful in managing compliance.
“It’s about setting their expectations and telling them that, if they do what they’ve been told, it will make their clinical procedure much more successful,” she said.
She added: “If they can get used to handling and putting drops in before surgery, when they have the additional drugs afterwards that’s just something else to add into the routine they’ve already got going.”
Hunter emphasised that compliance involves trial and error, and that explaining this to the patient can be helpful, so they are not put off if things do not go right the first time.
“It’s stressing to the patient how important it is to get the drops in, so they don’t run into problems with inflammation or uveitis. It’s [about] trying to make sure they do it,” she added.
What processes do the practitioners have in place to ensure their patients receive the right communication at the right time, pre-surgery?
Smith emphasised that her practice is on hand to answer questions or communicate with the provider if needed ahead of or after the pre-op assessment.
“I try and guide them, but the bottom line is, if they have any questions, come to us,” she said. “We’ve got their history, they are our patient, and we’ve referred them for that care. We are there to bridge the gap if there are any questions or queries.”
She added: “Pre-surgery, I’ll try and deal with as much as I can.”
If there are any concerns, she will contact the provider’s local representative.
Hunter agrees: “Forging good relationships with the treatment centres is key, as is getting information back from them. It’s a two-way street.”
As their surgery date approaches, Woodhouse believes most of his patients would be comfortable contacting the surgery provider themselves – but he is also more than happy to pick up the conversation if needed.
“The bottom line is that we’re always happy to talk to our patients,” he said. “There is no limit for them getting in touch with us.”
Post-surgery, how do practitioners welcome patients back into practice – and has that journey been consciously developed?
“You want your patient to come back so you’ve got that onward care,” Hunter said.
She added: “You want to touch base as soon as possible after their surgery, to make sure everything is alright, and so if they have any problems, they come back to you.”
Hunter reaches out to the patient as soon as she receives notification that the surgery is complete. A post-op check is then booked in.
Smith emphasises to patients that what they are experiencing – gritty or itchy eyes, for example – is normal, and wait until problems are resolved before discussing whether they need new glasses or if they should be referred for cataract removal on the second eye.
“It’s about being clear, and repeating advice,” she said.
“I make a point of telling the patient that the results I get during the post-operative check are sent back to the surgeon. I make it clear that that communication is there, and that any concerns will be flagged.”
It is vital to be aware that surgery is often emotional for patients, even though optometrists see it every day, Smith added.
In referring patients back to secondary care after surgery, Hunter emphasises that positive relationships can be hugely helpful – as can clear communication over what the issue is.
She is also on hand to follow up if the patient doesn’t hear from the hospital directly, she explained.
Hunter said: “It’s important that we make that link. The better communication you have with the hospital, the better service you can provide your patients.”
“THE BOTTOM LINE IS THAT WE’RE ALWAYS HAPPY TO TALK TO OUR PATIENTS”
Stephen Woodhouse, optometrist and director at Woodhouse Opticians, Blackpool
We want you to feel confident in our MiVOSMART products when managing childhood myopia.
That is why we generated a robust and wide spectrum of evidence, and the six year follow up clinical study, the longest study conducted on a myopia management spectacle lens ever.
Feel confident in your clinical practice, with MiYOSMART.

Effective myopia management solution for children, with robust and quality evidence to support it. • • -
Available in clear, polarised, and photochromic options to suit every child's needs.
Award-winning solutions endorsed by peers, experts and academic and industry organisations 0

Over 4 million lenses sold worldwide in over 30 countries.

EXAMS CLOSE: 28 DECEMBER 2023
The first instalment in this series of four articles on eyelid lesions will focus predominantly on the clinical characteristics of benign presentations.
Raman Malhotra FRCOphth and Ingrid Bekono-Nessah BSc, BMBSThe spectrum of eyelid lesions encompasses both benign and malignant tumours. Depending upon the underlying pathology, benign lesions can be classified as infective, inflammatory, traumatic, or neoplastic. Most eyelid lesions are benign. Nevertheless, their array of presentations and distribution patterns can make differentiating them from malignant lesions difficult. An appreciation of the varied appearances of benign lesions may circumvent the need for referral thus minimising patient anxiety and unnecessary investigation. The first two parts in this series of four articles on eyelid abnormalities will consider benign lesions while the latter two articles will direct attention towards malignant presentations.
Clinical evaluation of eyelid lesions begins by taking a thorough history (see Table 1). Epidemiologically, older patients are much more likely to develop malignancy and major risk factors should be considered; these include a personal or family history of skin cancer, solid organ transplantation, immunosuppression and exposure to carcinogenic environmental elements such as ultraviolet (UV) light and radiation.1 It is helpful to note the chronicity of symptoms and how the lesion has evolved. Rapid progression in size or colour should prompt further workup. Eliciting a precipitating event
such as local eye trauma or infection may support a benign cause. A history of
1 CPD POINT
prior failed treatments can also help to identify atypical or malignant lesions.
Onset May have distinct precipitating event, for example, trauma or infection
Patient demographic Young
Progression Usually non-progressive
Associated symptoms Painful Discharge Cellulitis
Response
Risk
Examination
Eyelashes Preserved
Lid margin Preserved
Specific signs Translucency
Insidious
Older
Progressive worsening of clinical features. In some cases, will be rapid
Painless Bleeding
Immunosuppression
Loss of eyelashes
Distortion of normal architecture such as cilia and gland orifices
Pearliness
Scarring in the absence of trauma
Ulceration
Telangiectasia
Diplopia
Proptosis
Mass Soft, well-circumscribed, mobileHard, irregular, non-tender
Tethering Non-tethered
Can be tethered to underlying structures
Colouration Uniform pigmentation if presentPigmented, multicoloured
TABLE 1 Summary of the clinical characteristics of benign and malignant lesions. Diplopia and proptosis suggest orbital invasion
50 Eyelid lesions: part one
56 Eyelid lesions: part two
60 Eyelid lesions: part three
64 Eyelid lesions: part four
While the focus of this article is on benign presentations, it is important for optometrists, dispensing opticians and contact lens opticians to be aware of the characteristics of malignant abnormalities so that these can be identified and managed accordingly. For instance, ulceration is seldom seen in benign lesions but is a hallmark feature of both non-melanoma and melanoma malignancy.2 Telangiectasia represents miniature blood vessels within the superficial dermal layer commonly seen in fair-skinned, sun-exposed, elderly individuals. Their presence overlying nodular, or irregular skin lesions is suspicious. Furthermore, erosion or destruction of the normal anatomy of the eyelid is a quintessential feature of basal cell carcinoma (BCC) or sebaceous cell carcinoma (SCC). Malignancy that has invaded the orbit may cause diplopia and proptosis. Pearliness caused by the hyperproliferation of cells in the basal epidermis may also be a feature of BCC. A good understanding of the eyelid anatomy is also important as the obliteration of the lash line or gland orifices is a concerning feature. Irregularity of borders arises from the variable proliferation rates of multiple cellular populations within a lesion. Hence, scalloped margins may be indicative of malignancy and should be viewed with concern if smooth borders begin to change in this way. Also consider any irregularity of contours resulting in a firm, non-symmetrical mass. Other significant features include lack of pain and the presence of bleeding. Non-uniform pigmentation is also suggestive of melanoma.
A chalazion is a sterile lipogranuloma caused by a meibomian gland blockage which leads to retention and stagnation
of sebaceous fluid.3 It is derived from the Greek word khalaza, which literally means a small knot.4 It may otherwise be known as a meibomian cyst or internal hordeolum. Meibomian glands are named after Heinrich Meibom (1638–1700), a German physician and professor of medicine, as well as history and poetry. Meibomian gland obstruction results in the sebaceous material within the gland expanding, causing swelling. A chalazion is initially painless but as the inflammation spreads to the surrounding tissues, secondary infection with local tenderness may develop. It may grow slowly over weeks to months and become firm but will often eventually resolve. When inflamed, with or without infection, it may burst through to the external (skin) or internal (tarsal conjunctiva) surface; this often allows it to resolve more promptly.
A number of conditions, like acne rosacea and blepharitis can predispose a person to developing chalazia, particularly in childhood and early adulthood.3,4 Other risk factors include seborrhoeic dermatitis, diabetes mellitus and pregnancy. Despite popular beliefs, the use of contact lenses or makeup have not been linked to an increased incidence of chalazia. During the COVID-19 pandemic, a phenomenon known as mask-induced chalazia emerged which researchers suggest may be caused by accelerated evaporation of the tear film promoting blepharitis and meibomian oil hardening.5,6
Given the fact that there are more meibomian glands in the upper eyelid, chalazia most commonly occur in this location and can persist for months, becoming chronic. Additionally, they may cause local skin irritation, and if sufficiently large, result in mechanical ptosis or corneal astigmatism. Because of the pressure generated by the enlarged glands on the cornea, wearing contact
LEARNING OUTCOMES
Practitioners will be able to identify the key questions that need to be considered in cases of eyelid abnormalities relative to their scope of practice
Practitioners will consolidate their knowledge on the key features of eyelid lesions and their management.
lenses can also be difficult. In the lower eyelid, mechanical ectropion may occur and can cause epiphora. Chronic chalazia may develop secondary calcification, which is seen in older patients. The development of malignancy with an initial formation of a chalazion is incredibly rare. On the contrary, it is important to recognise that chalazia may mimic sebaceous carcinoma, which typically will cause some destruction or distortion of the tarsus and posterior lamella. Therefore, clinicians should ensure they evert the eyelid to scrutinise the tarsus, even in cases of lower lid chalazion as observed in Figure 1 (see page 52).
An internal hordeolum is a term used to describe an infected chalazion. The term ‘external hordeolum’
has traditionally been used to describe infections of the sebaceous oil glands (glands of Zeis), which open into the eyelash follicles. While the term ‘external hordeolum’ has also been used in the past when a chalazion becomes infected and/or inflamed and erodes through the skin, nowadays, this term is best reserved for describing infections of the glands of Zeis. Typical infective bacteria include Staphylococcus aureus or Staphylococcus epidermidis
Overwhelming superimposed infection of a chalazion can also result in preseptal cellulitis, which would necessitate systemic antibiotics.
An uncomplicated chalazion is best managed conservatively with a warm compress to reduce inflammation.7 Recently, researchers have considered the use of intralesional steroid injection.8,9 While generally safe, triamcinolone acetonide commonly depigments darker skin. The application modality also poses a risk of inadvertent globe perforation, although rare if carried out by sufficiently trained medical personnel. Another rare complication is the microembolisation of steroid particles resulting in retinal or choroidal infarction and subsequent vision loss.
For chronic chalazion, a meta-analysis identified a greater rate of cure with surgery over intralesional steroids.8,9 Surgery may also be considered for large chalazia for which the preferred treatment is transconjunctival incision and curettage. Despite resolution rates above 90%, the benefits must be balanced with the risks of infection, bleeding, as well as the likelihood of further surgical revisions, lash loss or the development of subsequent pyogenic granulomas.



The pyogenic granuloma is another acquired inflammatory lesion characterised by lobular capillary proliferation.3 It is typically observed on the skin and mucosal surfaces following tissue damage such as surgery. Macroscopically it appears as an erythematous, vascularised lesion that is well-circumscribed and often lobular
in shape. Tarsal conjunctival pyogenic granuloma can occur secondary to a chalazion and can also appear rapidly following chalazion surgery.10 By everting the eyelid, it may be better observed, or otherwise noticeable if sufficiently large and protruding past the lid margin (see Figure 2). Notably, it contains friable vessels which are prone to painless bleeding. Patients may occasionally complain of a mild foreign body sensation. Pyogenic granuloma can mimic squamous papilloma which also tends to bleed, or malignant lesions, such as SCC or amelanotic melanoma, in which case a detailed history should be taken to elicit the traumatic precipitant. Once again, treatment is largely conservative, with small lesions often spontaneously resolving. Many pyogenic granulomas can be managed with topical
steroids, which are initiated at a high daily frequency and tapered down over weeks. Topical beta-blockers have also proven effective in inducing regression. Patients treated with timolol have shown significant reduction in intraocular pressure during treatment, but this normalises upon drop cessation.11 In the few instances where conservative management fails to induce regression, surgical excision may be considered.
Molluscum contagiosum (MC) is an infective lesion caused by direct contact with the pox virus mostly seen in children of pre-school age.12 In adults, cases are often seen in patients severely immunocompromised by acquired immunodeficiency syndrome (AIDS). Otherwise, there is no racial, geographic or sex predilection. Patients present with pale, waxy papules with a characteristic central umbilication (see Figure 3). Secondary follicular conjunctivitis can occur as virions are shed into the tear film but soon resolves after the lesions heal. Sometimes in chronic cases, the central umbilication can begin to ulcerate resembling a BCC and this should be actively excluded in more atypical cases arising in immunocompromised adult populations. Again, MC notably appears in multiples, in contrast to BCC which is usually a single lesion. It is also important to remember that BCC
does not cause follicular conjunctivitis. Diagnostic uncertainty should prompt a biopsy for histological confirmation; this will reveal a central cavity filled with sloughed-off epithelial cells that contain molluscum inclusion bodies within the cytoplasm. The infection can usually be contained by the local immune response though active management may involve surgical excision, curettage, or cryotherapy. Lastly, previous infection does not confer lifelong immunity and so patients should continue to adhere to careful hygiene principles around those with active disease.

Melanocytic naevi are benign tumours affecting up to 60% of adults and increasing in incidence with sun exposure.13 A naevus cell is an incompletely differentiated melanocyte. Naevus cells differ from mature melanocytes in the fact they are located around the dermo-epidermoid junction, arranged in clusters and lack dendrites. They are the primary component of cutaneous melanocytic naevi. Usually, acquired naevi become clinically apparent during adolescence as they become pigmented. They then evolve and progressively lose pigmentation thereafter (see Table 2). By age 70, the
majority have become amelanotic and migrated into the dermal layer.13 The histological location determines their potential for malignant transformation and clinical appearance although there is significant overlap in macroscopic appearance. In addition, the differential for a benign pigmented lesion is vast.
Albeit rare, melanoma should always be considered in patients presenting after the second decade of life with a new pigmented lesion. Most malignant melanomas arise de novo, although up to 30% develop from pre-existing naevi, and therefore, careful assessment of these lesions is imperative.14,15
The ABCDE approach has long been described to afford early detection of possible malignant melanoma (see Table 3, page 54). Designed for ease of assessment, the parameters included in the mnemonic are asymmetry, borders, colour, diameter and evolution. Like in Figure 4 (see page 54), typical melanocytic naevi tend to be symmetrical and well-circumscribed. Junctional naevi tend to be flat whereas compound naevi may be raised. Their colouration will likely evolve over their lifetime; however, the colour should always be consistent throughout the lesion. It would be atypical to see a naevus greater than 6mm and even more suspicious of malignancy if it had grown to this size in a short period. The history will guide the practitioner on how the lesion has evolved. It is important that practitioners appropriately
record their assessment of benign naevi so that comparisons can be made later. Other features outside of the ABCDE mnemonic are also important to elicit. For example, one should be mindful of the ‘ugly duckling sign’ – naevi that appear macroscopically different to surrounding moles. Cysts are reassuring features although their absence does not necessarily suggest malignancy. By contrast, feeder vessels are much less commonly seen with typical naevi and should herald consideration of an alternative diagnosis, as should bleeding tendency, oozing or pruritis.
A dysplastic naevus is a term recommended by the National Institute of Health, describing a naevus that behaves atypically.17 For example, it often grows larger than 5mm and can have ill-defined or irregular borders. Much like malignant melanoma, it may have varying intralesional colouration. Dysplastic naevi are thought to exist on a continuum between melanocytic naevi and multiple melanomas, and up to 18% of adults develop them. These individuals are at higher risk of developing malignant melanoma, though not necessarily through malignant transformation.18 Because they cannot reliably be distinguished
A Asymmetry: each half of the melanotic lesion is unlike the other
B Borders: the circumference of the lesion is irregular, scalloped, or ill-defined
C Colour: there is variation of colour within the lesion; this may include varying hues of brown, black, white, red or blue
D Diameter: length is greater than 6mm
E Evolution: changes in A–D over time or that isolate one lesion from the rest (‘ugly duckling’ sign)
Other Atypical location; ulceration; keratosis; discharge or bleeding
from malignant melanoma, all dysplastic naevi merit histological assessment and consideration for excision.
Reassuringly, most eyelid lesions are benign rather than malignant; however, practitioners should be alert to the presence of suspicious signs and symptoms during eye examinations, contact lens consultations and when dispensing or adjusting spectacles. In summary, lesions that bleed spontaneously are generally abnormal. Prior to this, malignant lesions may

ulcerate, or develop visible vessels known as telangiectasia. Lesions that appear to be benign, but which are resistant to treatment or persist despite normally self-resolving are also symptomatic of malignancy. Firmness and non-tenderness are concerning signs. If there is lid margin involvement, loss of normal architecture or lash loss is abnormal, as is pearliness or cicatrisation in the absence of trauma. Furthermore, malignant melanomas should be assessed using the ABCDE method, which evaluates asymmetry, irregular borders, colour variation, diameter over 6mm and evolution. Atypical or rare presentations are likely to lead to misdiagnosis, but through detailed history-taking and diligent ophthalmic examination, one should be able to identify red-flag features that warrant further investigation.
To read this article online, access the references and take the exam, visit: www.optometry.co.uk/cpd
Raman Malhotra is a consultant ophthalmic and oculoplastic surgeon at Queen Victoria Hospital NHS Trust, East Grinstead.

Ingrid Bekono-Nessah is a foundation year one doctor working within South London. She has a keen interest in anterior segment and paediatric ophthalmology.















The first article in this four-part series showcased common eyelid lesions, highlighting that most of these cases are benign in nature. Nevertheless, it is important for practitioners to be alert to indications of suspicious eyelid anomalies during the course of eye examinations, contact lens consultations, the dispensing process, as well as other interactions with patients, such as periodic spectacle adjustments.
Attention should be given to the timeline and evolution of the lesion, such as a change in colour or size, as well as establishing key risk factors, such as personal or family history of skin cancer, solid organ transplantation, immunosuppression and exposure to carcinogenic environmental elements such as ultraviolet (UV) light and radiation.
Part one in the series also demonstrated the need to be aware of key signs that can indicate a malignant presentation. In brief, these include the presence of telangiectasia, disruption of normal eyelid structures, such as obliteration of the lash line or gland orifices, or bleeding. Pearly or irregularly bordered lesions and nonuniform pigmentation should also heighten suspicion of malignancy.
Part two in the series will continue to focus on common benign eyelid lesions that can present in clinical practice.
Seborrhoeic keratosis (formerly referred to as basal cell papilloma) is the most prevalent benign skin lesion of the elderly.1 It frequently affects the face, trunk and extremities, and appears as a hyperkeratotic, pigmented
plaque. On the delicate skin of the eyelid, seborrhoeic keratosis can appear to be ‘stuck on’ with visible excrescences on its surface.2 It may otherwise appear pedunculated or lobulated. Among its distinguishing features, seborrhoeic keratosis frequently occurs in multiples, particularly with increasing age. A soft, oily lesion is a reassuring sign (see Figure 1); it also appears commonly on or below the pretarsal lid margins. Any lesion suspicious of melanoma should be assessed according to the ABCDE criteria outlined in part 1 of this series. Melanoma of the eyelid might be considered if the lesion has irregular borders with intralesion colour variation. If there is diagnostic uncertainty due to the presence of atypical features, a biopsy with histological evaluation will show enlargement of the epidermis owing to basal cell hyperplasia. Sometimes, keratin-filled horns or cystic inclusions may also be present. Most of these lesions, irrespective of their size, remain superficial and can be treated by shave excision at the dermal-epidermal junction. Alternatively, curettage, laser ablation or cryotherapy may be used.

The papilloma family of eyelid lesions is a group of benign epithelial proliferations. Treatment is usually not required except for cosmetic removal where cryotherapy or surgical excision may be offered.
Squamous cell papilloma (SCP) is otherwise known as a skin tag or acrochordon. Once again, it is more prevalent with advancing age. Most arise de novo but UV radiation and infection with human papillomavirus (HPV) are implicated in at least some cases.2 Sessile lesions often have a broad base and a smooth surface whereas pedunculated papillomas are rough in texture.3 They can be solitary, multiple, pigmented or flesh-coloured (see Figure 2). This hyperkeratotic lesion may resemble a squamous cell carcinoma (SCC), and crusting, ulceration and fissuring should warrant further investigation. Despite its many macroscopic appearances, histology of SPCs shows digitated projections of fibrovascular connective tissue encapsulated by irregular hyperkeratotic and acanthotic squamous epithelium.4 Surveillance is sufficient in most cases, although patients may prefer removal using

the aforementioned management techniques for benign epithelial hyperplasia.
Verruca vulgaris is another papillomatous lesion colloquially referred to as a wart, affecting approximately 10% of the global population within the first two decades of life.3 It is the result of an epidermal infection with HPV, particularly subtypes six and 11, which usually affect children and swimmers on the soles of their feet. The virus is spread by direct contact and one can selfinoculate the eyelid. Meat handlers and immunosuppressed individuals are also highly susceptible. In the early stages, the lesion appears flesh-coloured or grey and slowly enlarges to become an elevated papule with an irregular, digitated surface, usually on the eyelid margin (see Figure 3). Hyperkeratosis can resemble other benign papillomas, keratoacanthoma or SCC. Crucially, it may be differentiated by the preservation of eyelid architecture and their distinct borders. It is not usual to
see ulceration with verruca vulgaris, nor does it bleed or ooze. These lesions rarely require treatment although some patients may seek treatment for cosmesis, or if there is subsequent conjunctivitis due to viral shedding.

Epidermoid cysts are a type of keratinfilled sebaceous cyst lined with epithelium which commonly occur along the face, neck and upper back.5 Dermoid cysts are similarly lined but contain dermal appendages such as teeth, hair, and sebaceous glands. Epidermoid and dermoid cysts are examples of choristomas.6 In contrast to a hamartoma, which is a benign, non-cancerous mass of abnormal cells or tissue that normally occur within the involved site, a choristoma is a proliferation of histologically normal cells or tissue that are not normally found in the involved site. They are congenital cysts, accounting for most orbital tumours of childhood. They usually become symptomatic as they enlarge
Practitioners will be able to identify the key questions that need to be considered in cases of eyelid abnormalities relative to their scope of practice
Practitioners will consolidate their knowledge on the key features of eyelid lesions and their management.
with age; therefore, those presenting earliest are usually the most superficial. Dermoid cysts are most frequently found at the edge of the lateral brow, followed by the medial upper eyelid. Superficial lesions may also cause some overlying skin discolouration. Several characteristics may suggest their benign nature, such as their smoothness, mobility and slow growth. Posteriorly situated dermoid cysts do not present until adulthood as they become large enough to cause progressive proptosis. Computed tomography (CT) and magnetic resonance imaging (MRI) can help support the clinical diagnosis by determining the contents of the cyst. Small cysts may regress but large symptomatic ones require surgical excision. Rupture and incomplete removal during surgical excision may increase the likelihood of recurrence; therefore, care must be taken by the ophthalmic surgeon to avoid cyst rupture during excision.
Approximately 18% of excised periocular lesions are epidermal cysts, the second most common benign lesion of the area.7 Many of these cysts arise spontaneously from the infundibulum of the hair follicle but may also occur following sunburn or traumatic entrapment of the epidermal layer within the dermis. During the healing process, the ruptured epithelium releases keratin which triggers an inflammatory reaction, and a superimposed infection may occur. These epidermal inclusion cysts present as elevated, smooth papules.
Milia (see Figure 4) is a term used to describe an eruption of multiple epidermal inclusion cysts. Primary milia can present at birth, though it more regularly occurs later in life secondary to local trauma such as sunburn. Additionally, it may appear as a consequence of bullous disease healing. Usually, it self-resolves but patients may seek treatment for improved cosmetic appearance if nonremitting. Management options include needle marsupialisation, cryotherapy, laser resurfacing or dermabrasion. Confluent areas may be treated with a topical retinoid.
A cyst of Moll, or hydrocystoma, is a retention cyst in the sweat gland of Moll caused by a blockage in the draining duct (see Figure 5).7,8 Either eccrine or apocrine sweat glands are affected. Eccrine hydrocystomas present as small, soft eyelid lesions predominantly affecting the lower eyelid and medial canthus with eyelid margin sparing. Apocrine hydrocystomas characteristically present as firm, transilluminating eyelid margin lesions and may have a bluish colouration with yellow deposits within. They may appear as solitary or multiple lesions. The important malignant differential to consider with these lesions is cystic basal cell carcinoma (BCC), particularly if there is associated
telangiectasia and pearliness of the skin.9 Reassuring features of a benign cyst include preservation of the eyelid margin and lash line. Hydrocystomas are typically diagnosed clinically but uncertainty should trigger a biopsy for confirmation. Although benign, ocular pruritus or cosmetic impact may incentivise patients to seek a cure by excision. Similarly, obstruction of ductal outflow of the sebaceous gland of Zeis can lead to cyst formation. The two can be differentiated by the lack of transillumination seen with cysts of Zeis as they are filled with yellow, turbid material. Infection of a cyst of Zeis or Moll results in the formation of an external hordeolum.


Xanthelasma palpebrarum are localised accumulations of lipid-laden macrophages that form in the medial canthus of the eyelids.10 Typically, these lesions are symmetrically distributed around both eyes and may be solitary or multiple (see Figure 6). They are often observed following the fourth decade of life and do not cause ocular symptoms or side effects. Xanthelasma is associated with dyslipidaemia, particularly hypercholesterolaemia, and
therefore, may indicate an increased risk of atherosclerotic disease. It is, therefore, prudent to screen patients for lipid disorders and this may result in subsequent diet modification and consideration for lipid-lowering medication. These asymptomatic lesions may be removed by excision, radiofrequency dermabrasion or Argon laser photocoagulation if cosmetically bothersome.11 Following surgical excision, recurrence is common. Radiofrequency abrasion is increasingly used nowadays as it results in less scarring in comparison to other ablative
treatments, such as chemical acid peels; however, any form of ablation may also lead to post-treatment hypo- or hyper-pigmentation.
Actinic keratoses are premalignant lesions that typically arise in anatomical areas of high sun exposure, for example, the dorsum of the hand, shoulder and face.12 Around the eyelid, they can appear as solitary or multiple, pigmented, ovoid plaques with overlying scaling and sandpaper-like texture (see Figure 7). Adjacent skin usually shows signs congruent with UV exposure such as telangiectasia and yellow discolouration. They may also give rise to a cutaneous horn. On occasion, actinic keratosis with heavy pigmentation may resemble lentigo maligna. Fewer than 1% of these lesions transform into sebaceous cell carcinoma (SCC) per year.2 When differentiating an actinic keratosis from a malignant lesion, note that they are slow-growing and have distinct borders. They predictably darken with sun exposure and cosmetically improve with sun avoidance.2 Histopathological assessment should be considered if the clinical examination is inconclusive.
Actinic keratosis exhibits cellular atypia resulting in an irregular dysplastic epidermis with hyperkeratosis. Of note, invasion of the stroma would indicate SCC.
They can be treated with ablative therapies such as cryotherapy,
curettage, laser or numerous topical agents including 5-fluorouracil (5-FU), diclofenac and imiquimod cream; these are beneficial for patients who have multiple lesions. The advantage of using topical agents is that field-based treatment may also target subclinical actinic keratoses in the area, decreasing their recurrence and opportunity for malignant transformation.13 Topical 5-FU and diclofenac 3% cream have similar dosing regimens, requiring patients to apply the cream to the affected area multiple times a day for one month; this can be rather bothersome for patients and may lead to non-compliance. The latter is not suitable for pregnant women and so diclofenac may be suggested which necessitates concurrent sun protectant use. Imiquimod cream (trade name Aldara) is a good, is a good alternative for the eyelid and is as successful as 5-FU in the long-term at preventing the development of actinic keratoses.13 Dosing is weekly which reduces skin irritation in the area. However, it is usually continued for three to four months. Ophthalmologists will often opt for local excision of small lesions close to the lid margin as topical treatments may cause ocular irritation.14
Nicotinamide is a derivate of vitamin B3 that actively protects cells from UV radiation-induced damage.15,16 It supports deoxyribose nucleic acid (DNA) repair following UV irradiation by ensuring there is sufficient generation of adenosine triphosphate (ATP) to enable the energy-intensive process of DNA repair. Optimising DNA repair processes reduces carcinogenesis. It is obtained exogenously from meat, fish and nuts. Oral nicotinamide, therefore, represents a readily available treatment option for patients at high risk of developing non-melanoma skin cancer and may encourage regression of actinic keratosis.
Practitioners should be reassured that the majority of eyelid lesions seen in clinical practice are benign. Nevertheless, it is essential to remain alert to the characteristic features of malignancies during patient interactions by having awareness of risk factors and potential signs.

To read this article online, access the references and take the exam, visit: www.optometry.co.uk/cpd

The third article in this four-part series on eyelid lesions will highlight the key features of malignancies that may present in practice along with their treatment.
structures by progression of the lesion may result in diplopia and proptosis.
As demonstrated in parts one and two in this series of four articles, most eyelid lesions are benign. Articles three and four in the series will explore a range of malignant eyelid lesions, highlighting the key features in these cases.
In the Western world, the most common eyelid malignancy is basal cell carcinoma (BCC), accounting for 80–95% of eyelid malignancies.1 The remaining malignant tumours are much rarer in comparison and include squamous cell carcinoma (SCC) (<5%), sebaceous gland carcinoma (SGC) (13%) and malignant melanomas (1%). This is in contrast to the literature arising from Asian countries where SGC constitutes approximately 70% of eyelid tumours.2,3 Early recognition of potentially malignant lesions allows prompt assessment and management, thus improving outcomes. Malignant eyelid lesions can be both sightthreatening, leading to orbital invasion and exenteration, and life-threatening through distant metastases, emphasising the need for optometrists, dispensing opticians and contact lens opticians to be alert to these presentations during their interactions with patients.

As highlighted earlier in the series, taking a thorough history is an essential starting point when assessing eyelid abnormalities. Practitioners should explore the potential for predisposing risk factors such as a personal or family history of skin cancer, solid organ transplantation, immunosuppression and exposure to carcinogenic environmental elements such as ultraviolet (UV) light and radiation. It is prudent to note the chronicity
initially thought to be a chalazion and exhibited no rapid changes. However, it was unresponsive to treatment. On examination, there is central ulceration with lash loss. It required biopsy for diagnosis
of symptoms and how the lesion has evolved. Rapid progression in size or colour should prompt further workup. Eliciting a precipitating event such as local eye trauma or infection may support a benign cause. A history of prior failed treatments also helps to identify atypical or malignant lesions. While malignant eyelid lesions may not always abide by specific rules, there are characteristic features that should be assessed and escalated accordingly. For instance, ulceration is the result of the disorganised proliferation of malignant cells causing them to outgrow their arterial supply and become ischaemic.4 It is seldom seen in benign lesions but is a hallmark feature of both non-melanoma and melanoma malignancy. The presence of telangiectasia overlying nodular, or irregular skin lesions should arouse suspicion, as should erosion or destruction of the normal anatomy of the eyelid, which are classic features of BCC or SCC. Delay in diagnosis of aggressive subtypes can lead to significant advancement, radical resection, and poorer cosmetic outcomes, while invasion of orbital
BCC is the most common periocular malignancy, accounting for ~90% of malignant neoplasms in the periocular region and 20% of overall BCCs.5,6 The typical patient is a fair-skinned older individual. A key risk factor for the development of BCC is intermittent intense UV radiation, as well as a history of childhood sunburn. It is understood that shorter-wavelength UVB radiation plays a greater role in the pathogenesis of BCC than longer-wavelength UVA by causing deoxyribose nucleic acid (DNA) damage, disabling its repair system, and causing immunomodulation such that there is progressive acquirement of carcinogenic genetic alterations.7 For example, greater than 50% of BCC lesions show a mutation in the TP53 tumour suppressor genes. Specifically, such mutations activate hedgehog intracellular signalling pathway genes such as patched Ptch-1 which promote eyelid BCC. Arising from the abnormal proliferation of basaloid epithelial cells, they are characterised by peripheral palisading cells and random central organisation.
BCCs occur most frequently on the lower eyelid (50%) followed by the medial canthus (30%), upper eyelid (15%) and lateral canthus (5%).4 Medial or lateral canthal BCC are more likely to invade the orbit due to incomplete excision of the deep component. Extra care should be taken with the management of BCC in this area. There are over 26 different subtypes of BCC described in the literature, but the more common, distinctive, clinicopathologic types include: nodular, micronodular, superficial, infiltrative, morpheaform (infiltrative with sclerosis) and basosquamous.8 A BCC often has components of more
than one subtype. Ulceration may be present in larger lesions and occurs as a result of the central core outgrowing its blood supply as the tumour grows outwards. The superficial subtype has multiple, small buds of basaloid cells descending from the epidermis with no dermal invasion. These are often difficult to surgically excise completely. The micronodular subtype has histologic features similar to those of the nodular subtype, except that it is composed of multiple small nodules, and therefore, a high risk for local recurrence. The sclerosing (morpheaform) subtype is composed of basaloid cells that invade the dermis, surrounded by dense fibrous stroma; they invade and infiltrate deeply. BCC may also be pigmented due to the presence of melanocytes and melanin, and can, therefore, mimic melanoma. Another variant is the basosquamous BCC which shows features of both BCC and squamous cell carcinoma (SCC).

The nodular subtype is by far the most common and accounts for over 70% of cases. It preferentially affects the lower eyelid, followed by the medial canthus, upper eyelid (see Figure 1) and lateral canthus. It appears as a raised pearly nodule with associated telangiectasia and ulceration. In general, nodulartype BCCs are slow growing and rarely metastasize. In 10% of cases, infiltrative

or morpheaform type BCC occur in many forms.4 They are usually raised, firm, indurated, flesh-coloured with indistinct edges, which can often resemble cicatrisation (see Figure 2).9 Morpheaform-type BCCs tend to be more locally aggressive. Factors that may suggest its presence include large size, recurrence and associated inflammation. Other aggressive features include perineural invasion and increased immunohistochemical expression of Ki-67, a marker of proliferation.
Orbital invasion is an extremely rare complication of BCC occurring in fewer than 5% of cases, particularly those that are locally aggressive histological subtypes, recurrent, or involving the medial canthus.10,11 Signs of this include restrictive strabismus, globe displacement or destruction, or the presence of a fixed orbital mass. Computerised tomography (CT) is useful in delineating bone involvement, whereas magnetic resonance imaging (MRI) better visualises soft tissue orbital involvement. Invasion beyond the level of the orbital septum renders local excision difficult.
High-frequency ultrasound (HFUS) is a promising novel imaging technique that permits invivovisualisation of skin lesions, allowing the determination of size, shape and volume. Exvivousage may also be beneficial to surgeons
Practitioners will be able to identify the key questions that need to be considered in cases of eyelid abnormalities relative to their scope of practice
Practitioners will consolidate their knowledge on the key features of eyelid lesions and their management.
by allowing them to confidently resect skin tumours with adequate margins. Invivoreflectance confocal microscopy has also shown promise in the investigation of eyelid lesions by reducing unnecessary biopsies with 100% sensitivity and 70% specificity for tumours in the region.12 However, at present, eyelid BCC is best managed by margin-controlled excision, whereby, the repair is only embarked upon following histological confirmation of clearance.
Owing to their incredibly visible nature, periocular malignancies require careful surgical planning to ensure good oncological control, cosmesis and minimal functional disruption to neighbouring structures. Generally, enfacehistological margin examination rather than bread-loafing histological assessment allows greater assessment of the outer surface of the excision specimen. Margincontrolled excision and repair remains the most important
principle to reduce recurrence. UK National Multidisciplinary Guidelines recommend that non-infiltrative BCCs less than 2cm in size, outside the eyelid region be removed with margins of 4 to 5mm.13 Smaller margins are considered in cases where reconstruction may prove difficult. A large multicentre review found that at margins of 2mm, the complete excision rate of periocular BCCs was just 83.7%.14 Furthermore, there is a significantly high rate of recurrence with wide local excision (WLE) and immediate repair for BCC; this is likely due to incomplete excision and sampling errors introduced by the bread-loafing technique commonly used to assess margins in WLE.7
Mohs excision is a labour-intensive process that results in the highest cure rate with maximum preservation of tissue. Using the same principles as enfacemargin analysis, either frozen-section controlled excision or excision with rush-paraffin sections and delayed repair achieve the same outcomes. Given that reconstruction of eyelid defects is often complex and further excision thus compromises reconstructive options and outcomes, margin-controlled excision is far more preferable to the traditional methods of WLE and immediate repair for BCC of the eyelid region.


When there is orbital infiltration, it may be difficult to obtain orientation of specimens from soft tissue, making Mohs or other types of frozen-section excision inappropriate. Often, these patients require focal orbitectomy surgery (localised removal of the involved orbital tumour). If extensive tumour involvement exists, orbital exenteration surgery (removal of the entire globe and orbital contents) may be necessary, with or without adjuvant radiotherapy.
Many other adjuvant therapies exist which are typically used in the context of inoperable tumours. For instance, Vismodegib is a hedgehog pathway inhibitor that can halt the growth of extensive, large periocular BCC where surgical excision may
not be possible. It is generally well tolerated and administered orally.15 It is expensive and side effects may include alopecia, muscle spasms, diarrhoea and constitutional symptoms. For less advanced superficial BCC, 5% imiquimod, a modulator of the immune system which induces apoptosis of tumour cells, is often used for BCC away from the eyelid margin. A clinical trial demonstrated 90% efficacy in managing BCC where surgery is inappropriate.16
Linear BCC describes a particular appearance of BCC that presents as a straight lesion with a 3:1 lengthwidth ratio.17 It affects the lower eyelid most commonly and runs along the tear trough groove with significant subclinical extension (see Figure 3). Sometimes these may have a nodular component but usually they are indurated. Although they appear innocuous, they display aggressive tumour behaviour and similarly require margin-controlled excision.
SCC is the second most common eyelid malignancy, after BCC. Although occurring far less frequently than BCC, recent decades have seen an increasing incidence rate of approximately 2% per annum;18 this is thought to be due to an ageing population, who experience the consequences of cumulative exposure to environmental agents such as UV light, and less so, arsenic and hydrocarbons. Additionally, human papillomavirus (HPV) and human immunodeficiency virus (HIV) appear to be independent risk factors for SCC.19 There is also a well-established relationship between solid organ transplantation and SCC development, particularly among those receiving lung and heart transplants in which the SCC incidence is reportedly 30% and 26% respectively.20 This finding is most likely due to the immunosuppressive medications used in the post-transplant period which impair the ability of the immune system to halt carcinogenesis. In fact, any form of long-term immunosuppression medication increases the risk of developing SCC. There also appears to be a sex predilection, with males twice as likely to develop eyelid lesions than females.18 Other intrinsic risk factors for SCC include albinism due to the lack of melanin that otherwise provides a barrier to UV light, and xeroderma pigmentosa, most likely due to the build-up of unrepaired DNA damage.

In comparison to BCC, SCC is a cancer of the cutaneous squamous cells which form the superficial epidermis.20 It is often described as the endpoint of a spectrum of disorders including actinic keratosis (AK), Bowen’s disease and keratoacanthomas. AK is a precancerous lesion arising in areas of sun exposure. Bowen’s disease, otherwise known as carcinoma insitu, describes fullthickness epithelial dysplasia that can significantly spread laterally but also deep into pilosebaceous units despite not technically invading the dermis.21 Therefore, their deep extension may be within the depth of dermis while not having invaded the dermis itself. Such lesions have atypical architecture
but do not show evidence of local or regional spread. Macroscopically, it appears as a pigmented or erythematous macule and can be mistaken for inflammatory lesions like psoriasis or eczema. Its development is strongly associated with the presence of HPV subtype 16. Keratoacanthoma has most recently been described as a welldifferentiated SCC. It is a hyperkeratotic lesion which may have neutrophil infiltration. Often, the base of the lesion is well-demarcated from the adjacent dermis by inflammation on histology. It classically appears dome-shaped with central keratosis and ulceration. Ulceration is a key feature that should cause one to question its benign nature. A biopsy is required for the differentiation of keratoacanthoma and SCC. Many ophthalmologists will choose to monitor small keratoacanthomas in a bid to circumvent the need for surgery and the resultant negative sequelae.
Finally, SCC, a malignant lesion extending into the dermis with differentiation ranging from mild, moderate to poor, lacks any typical macroscopic pathognomonic features to differentiate it from precursor lesions (see Figure 4). SCC may also appear similarly to BCC, predominantly affecting the lower eyelid in 60% of cases.19 Commonly, it presents as a painless scaly, nodular lesion with irregular borders. Its irregularity and painlessness should lead one to query malignancy. More insidious lesions may
present as madarosis (loss of lashes) or distortion of eyelid architecture. Histologically, the malignant cells are large and show prominent eosinophilic cytoplasm with a high nuclear-tocytoplasmic ratio. Keratin pearls are concentric rings of squamous epithelial cells that show progressive keratinisation; these are commonly found in well-differentiated squamous neoplasms and sometimes observed also in SCC, and BCC. Assessment should include a full ophthalmic examination and palpation of regional lymph nodes due to its tendency for lymphatic spread.
The primary treatment modality for confirmed SCC remains surgical excision with margin-controlled excision. Patient education on avoiding UV exposure is the key to prevention. Where surgical complete excision is not possible, epidermal growth factor receptor (EGFR) tyrosine kinase inhibitors such as cetuximab, erlotinib, and gefitinib have shown promise.22,23 SCC involving the head and neck appears to have a more aggressive phenotype than other anatomical regions. Periocular SCC can lead to severe morbidity through orbital invasion as well as cerebral and sinus invasion. As with BCC, surgery can also lead to significant problems with cosmesis and function, including eyelid closure and dry eye.
This article highlights the hallmarks of a range of malignant eyelid lesions that may present in clinic.
Practitioners should pay particular attention to lesions that bleed, have an ulcerated or telangiectatic appearance along with those that appear to be benign but are unresponsive to treatment. In addition, disruption to normal lid architecture, loss of lashes and lesions with irregular borders should also heighten the suspicion of malignancy.
To read this article online, access the references and take the exam, visit: www.optometry.co.uk/cpd
Introduction
The previous articles in this fourpart series highlighted that although benign lesions comprise the majority of eyelid abnormalities, it is important for optometrists, dispensing opticians and contact lens opticians to be alert to the hallmarks of malignancy during their interactions with patients.
Key points to consider in the history include:
• Personal or family history of skin cancer
• Solid organ transplantation
• Immunosuppression
• Chronicity and evolution of the lesion.
Practitioners should be alert to the following signs which raise the suspicion of malignancy:
• Bleeding
• Pearly appearance or irregular borders
• Non-uniform pigmentation
• Presence of overlying telangiectasia
• Disruption of normal eyelid appearance.
Practitioners should also be mindful that malignant lesions may not always abide by specific rules and can present with unique characteristics.
Continuing from part three, this final article in the series will present further cases of eyelid malignancies.
The most common eyelid malignancy in the Western world is basal cell carcinoma (BCC), accounting for 80–95% of eyelid malignancies.1 Other malignant tumours are much rarer

typically involve the upper eyelid and are one of the commonest eyelid malignancies in Asia. Always consider this as a differential diagnosis for BCC or SCC of the upper eyelid as it commonly masquerades as either. It may also be misdiagnosed as unilateral blepharitis or chalazion. It characteristically erodes the tarsus and is fatal via metastatic spread and high recurrence. Suspicious lesions must be completely excised and staged

In the final instalment in the series, this article continues to showcase cases of malignant eyelid lesions and treatment options.FIGURE 1 SGCs
in comparison and include squamous cell carcinoma (SCC) (<5%), sebaceous gland carcinoma (SGC) (1-3%) and malignant melanomas (1%). The literature shows that in contrast to the West, SGC constitutes approximately 70% of eyelid tumours in Asian countries.2,3
Periocular SGC arises from the sebaceous glands that line the eyelid margins (see Figure 1). Most commonly they occur in older individuals of Asian descent, and it is believed that over half the malignant eyelid tumours investigated in India are SGCs. The presence of SGC in a young patient or a family history of malignancies should raise the possibility of the condition, hereditary non-polyposis colorectal cancer (HNPCC), also known as Lynch syndrome. Muir-Torre syndrome is an autosomal dominant phenotypic variant of Lynch syndrome where a greater risk of sebaceous neoplasms and internal malignancy exists.4 MSH2, MLH1 and MSH6 are tumour suppressor genes responsible
for DNA mismatch repair that are mutated in the condition. Although the disease is usually inherited in an autosomal dominant pattern, sporadic cases have been reported in patients undergoing renal transplants and taking immunosuppressing medications.5 Such patients require increased surveillance for malignancy and familial genetic testing.
Sebaceous carcinomas can be difficult to differentiate from a chalazion, which can delay diagnosis of this potentially lethal malignant lesion. Like a chalazion, SGC commonly arises in the upper eyelid due to the greater number of sebaceous glands in this region. The sebaceous content is lipid-dense and can appear yellow. SGC should be suspected in a young patient of south-east Asian origin, or if a nodule precedes the onset of a chalazion with progressive effacement of the gland orifices, destruction of cilia follicles and lash loss. It should also be considered if there is a



LEARNING OUTCOMES
Practitioners will be able to identify the key questions that need to be considered in cases of eyelid abnormalities relative to their scope of practice
Practitioners will consolidate their knowledge on the key features of eyelid lesions and their management.
“THE MOST COMMON EYELID MALIGNANCY IN THE WESTERN WORLD IS BASAL CELL CARCINOMA (BCC), ACCOUNTING FOR 80–95% OF EYE LID MALIGNANCIES”FIGURE 2 Lentigo maligna melanoma. Left: clustered brown patches with keratosis. Any existing nodularity is particularly suggestive of malignancy and warrants biopsy. Middle: the defect was subsequently excised. Right: repair with a cheek-flap running from the patient’s jawline
paucity of discharge or where imaging reveals a large solid component to the lesion. A pagetoid tumour is poorly differentiated, has a higher chance of metastasising and can extend into the epidermis from the tarsal plate. Intraepidermal malignant cells can result in marked conjunctival inflammation and injection; this can mimic chronic blepharitis or superior limbic keratoconjunctivitis. Be wary of seemingly benign lesions that do not respond adequately to treatment and importantly, always consider SGC
where unilateral blepharitis appears to be present. A biopsy of suspicious lesions is always required, and for SGC, this is usually full-thickness rather than a superficial shave, in order to sample the posterior lamella. Sebaceous carcinoma has multiple histopathological patterns with the lobular type being the commonest. Although basophilic pleomorphic cells with vacuolated cytoplasm, prominent nucleoli and mitotic structures are classically observed in sebaceous carcinoma, these non-
specific features may also be observed in BCC and SCC. Considering this, immunohistochemistry has proved helpful in confirming the diagnosis as adipophilin and epithelial membrane antigen (EMA) can distinguish it from other eyelid malignancies. Patients often require staging with magnetic resonance imaging (MRI). Management requires surgical excision with margin-controlled, ideally with rushed-paraffin sections, rather than rapid frozen sections. Where intra-epithelial conjunctival

spread is suspected, then conjunctival map biopsies are also performed to exclude pagetoid conjunctival involvement. If present, this is usually treated with adjunctive topical mitomycin-C drops. Prognosis is generally good although there is up to a 25% rate of recurrence, which is far greater than most eyelid malignancies.6-8 Some individuals may require orbital exenteration if orbital involvement is present.
Eyelid melanoma accounts for only 1-2% of malignant neoplasms in the area.9 Like cutaneous melanoma of other bodily sites, these melanocytic tumours can behave aggressively, harbouring the potential to metastasise both locally, to adnexal and orbital structures, and distally, via haematogenous and lymphatic spread to the liver, lung, bone and brain. Rarely, systemic conditions such as familial atypical multiple mole melanoma syndromes, familial melanoma and xeroderma pigmentosum predispose individuals to eyelid melanoma.10 Fair skin, a history of childhood sunburns and ultraviolet (UV) radiation are more frequent risk factors. There may also be an increased lifetime risk for males. A dermatological history of non-melanoma skin cancer and dysplastic naevus also increases risk. In more than half of advanced cases, certain mutations are found which activate downstream mechanisms culminating in increased cellular proliferation. There are numerous clinicopathological forms of eyelid melanoma but perhaps the most relevant subtypes are lentigo maligna melanoma, nodular and superficial spreading. Lentigo maligna is a premalignant lesion that exists on the
spectrum of melanoma disorders and describes a melanoma in situ, akin to Bowen’s disease of SCC.11 It was traditionally known as Hutchinson’s melanotic freckle.12 Once again, the major risk factors are advancing age and chronic sun damage. Lentigo maligna is characterised by aberrations in its borders and pigmentation.13,14 Often it presents as a slow-growing macule on the lower eyelid.15,16 Histopathologically, there is uncontrolled proliferation of melanocytes within the epidermis causing hyperplasia and dysplasia portrayed by nuclear pleomorphisms and changes in nuclear size and shape.12 There is insufficient guidance on the management of this condition in the periorbital region, but recommendations suggest excision and ongoing monitoring to mitigate the risk of malignant transformation. This precancerous lesion should not be confused with lentigo maligna melanoma, which refers to melanoma that has breached the basement membrane (see Figure 2). It is the most prevalent subtype of melanoma arising in the eyelid (but least common overall) and the terminus of up to 50% of precancerous lentigo maligna.12 Nodularity arising within lentigo maligna is highly suspicious of malignancy; however, its absence does not exclude malignancy and large melanomas in situ are also alarming features of underlying malignancy.9 Furthermore, the pigmentation may extend over the eyelid margin and involve the conjunctiva, known as primary acquired melanosis (PAM) with atypia. Lentigo maligna melanoma mandates surgical excision following histological diagnostic confirmation.
Fewer than 10% of eyelid melanomas are of nodular subtype,12 which
makes diagnosis and treatment more challenging as eye care specialists are less familiar with their presentation, particularly as they can be amelanotic. Conversely, the nodule may appear blue or black which should always raise suspicion. Once again, nodularity represents the vertical invasive growth phase, which is a presenting feature of this subtype. Hence, they have likely invaded deep into the dermal layer at the time of diagnosis and confer a dismal prognosis.
Superficial spreading melanoma is the commonest type overall but an incredibly rare diagnosis for an eyelid lesion. Histology shows clusters of epithelioid cells scattered throughout the epidermis and they exhibit vertical growth less frequently than the nodular type. Clinicians should be wary of patients presenting with plaques with irregular borders and varied pigmentation (see Figure 3).
If concerned, clinicians must arrange for histological assessment of a punch-trephine or incisional biopsy sample. A superficial shave biopsy has no role where melanoma is suspected; this is because calculation of the Breslow score, a measure of the depth of the lesion, is one of the most influential prognostic markers of this disease. In addition, reflectance confocal microscopy, impedance spectroscopy and digital microscopy (dermoscopy) have shown promise in increasing diagnostic certainty. Dermoscopy is now well-established as an important tool in assessing melanocytic lesions. Figure 4 (see page 68) shows a sequence of images from presentation through to biopsy, complete excision, reconstruction and skin graft.
Margin-controlled excision with rushed-paraffin sections and not rapid frozen-sections forms
“IF CONCERNED, CLINICIANS MUST ARRANGE FOR HISTORICAL ASSESSMENT OF A PUNCH-TREPHINE OR INCISIONAL BIOPSY SAMPLE”
excision and confirming clear margins. Middle: reconstruction of posterior lamellae and orbicularis oculi. Bottom: one month following skin graft
the cornerstone of management with consideration for sentinel lymph node biopsy if necessary. Freitag et al recently stated that approximately 20% of eyelid melanomas invade local lymph nodes and immunohistochemistry staining against melanoma antigens S100, Melan A and HMB45 in lymph node biopsies
can aid in detection.17,18 Alkylating chemotherapeutics have long been used first line for the medical management of melanoma and include drugs such as dacarbazine. More recently, biological checkpoint inhibitors and MEK inhibitors have been used in cases of eyelid melanoma.19,20 Prognostication is determined by subtype, the
involvement of the eyelid margin, depth of invasion (Breslow score) and presence of ulceration.11 Local and distant invasions are also likely to be relevant to prognosis. Local recurrence is most likely to occur within five years of surgery and patients should be monitored throughout this period. In 2021, the largest analysis of cutaneous melanoma of the eyelid showed the five-year overall survival rate was 88.6% for melanoma in situ and 77.1% for invasive melanoma. However, older cases were included in this analysis from an era of poor melanoma prognosis. The study also found that age ≥75 years at diagnosis, T4 staging, lymph node involvement, and the nodular melanoma histologic subtype are harbingers of poor survival.21 The authors have recently published their series of 22 eyelid melanoma cases using margincontrolled excision. They observed a 36% recurrence rate within 24 months and a survival rate of 90% with minimum five-year follow-up.22
The final instalment in this four-part series on eyelid lesions reinforces the need for practitioners to be ever watchful for signs and symptoms that differentiate malignancies from seemingly benign cases in order to offer timely intervention and maximise the prognosis for patients.




To read this article online, access the references and take the exam, visit: www.optometry.co.uk/cpd

“BE EVER WATCHFUL FOR SIGNS AND SYMPTOMS THAT DIFFERENTIATE MALIGNANCIES FROM SEEMINGLY BENIGN CASES”





20 Individually Wrapped Pre-Moistened Towelettes







“MY












Götti has created a fivepiece eyewear case that can be assembled in practice. Designed for the sustainable Götti Bionic collection, the new case takes up less space in transportation and practice. Including a vinyl leather case, button closures and cord, the case can be assembled horizontally or vertically. www.gotti.ch

SPECTACLES
BondeyeOpticalhas introducedanindirect ophthalmoscopebyHeine Optotechnikthatisdescribed asidealforpatientswhoare unabletouseslitlamps. Theinstrumentfeaturesa stereoscopicadjustment functiontoprovidea wideview.
www.bondeyeoptical.co.uk
Atlantic Optical has partnered with the Ocean ConservationTrust to support the protection of seagrass meadows through sales of the new bioacetate Big &Tall Eco collection. www.atlanticoptical.co.uk
LOW VISION AID
OrCamTechnologies has launched a new reading device for people with vision loss or reading fatigue.The OrCam Read 3 combines a handheld voice-activated reading companion, magnifier, and a reader stand. www.orcam.com


OGI Eyewear has released a virtual try-on app for optical professionals. Using the app, patients can access hundreds of styles and colour options, experiencing a 360-degree virtual view, and send screenshots.
www.ogieyewear.com







New options in orthokeratology and myopia management, an easy-to-fit tailored lens, compliance kits and an educational podcast

Bausch + Lomb has launched a patient leaflet illustrating contact lens insertion and removal while also reinforcing safety messages. Until the end of the year, when ordering a Biotrue starter kit for patients, practices can add the leaflet and a goody bag. www.bausch.co.uk/ biotruempsecp

No7 CooperVision Specialty EyeCare has introduced the EyeDream MC.The orthokeratology lens is recommended for new myopia management fits, as well as for existing wearers of the original EyeDream lens who are progressing faster than the eye care professional would like.
www.no7contactlenses.com
Johnson &Johnson Vision has produced a new podcast: Vision Matters. Eye care professionals in the UK can gain one CPD point by listening to an episode and completing an accompanying exercise. www.jnjvisionpro.co.uk

Positive Impact has introduced two new contact lenses from pharmaceutical company,Tiedra, into the UK market.The Alexa AR is a rigid gas permeable orthokeratology lens, while the Esencia contact lens is CEmarked for myopia management in children and teenagers. www.positiveimpact.co.uk

Menicon Niji, launching this autumn, is a custom soft monthly silicone hydrogel lens that the company suggests is easy to fit and specially tailored for simple and complex prescriptions. www.menicon.co.uk/professional


IHave you been diagnosed with Glaucoma?




The NEW Direct Selective Laser Therapy (DSLT) is a rapid, pain free procedure that takes just a few seconds per eye and may eliminate or reduce the need for eye drops.












The British triathlete and two-time Olympic gold medal winner told OT about the importance of sunglasses as an athlete


Partnered with:


Oakley
Number of frames: “Probably hundreds”


What does vision and eye health mean to you?
I live to be outside and enjoy the view. Vision and eye health couldn’t be more important to me.
I probably have hundreds of sunglasses. Oakley is a partner of mine and I’m very lucky to have a different pair for every condition possible. I think functionality is the main thing when it comes to eyewear, and thankfully, all Oakley frames look good.

It is hard to beat a classic ‘Radar’ frame for cycling and running. My favourite is the ‘Radar EV’ in white with Prism lenses. These are perfect for all the light and weather conditions we get inYorkshire.
My understanding of the benefits of eyewear as an athlete came when I realised I was spending hours outside every day. Oftenoversixhoursinverybright conditions.Iwasalmostpermanently squinting.Iwasalsoconstantlygettingdirt andinsectsinmyeyesduringbikerides.
I have three tips for selecting the right frames: Do they fit your head? Can you feel them when they are on? Is the lens tilt right to make sure light doesn’t come through the top?
In this edition, we are exploring what it means to learn from challenges. As an athlete facing huge pressures, how would you describe your relationship with ‘failing’?
However successful your sporting career is, you’ve failed much more than you have succeeded. Failure is part of my life. I try not to get too upset about things that haven’t gone to plan and don’t allow myself to reflect on them too much. Instead, I try to learn what I can and crack on with the next goal.









































































































Bayria Eyewear created ‘AnnAcronista,’ which pays homage to the late Italian fashion-writer Anna Piaggi. bayriaeyewear.com






Vinylize has released an eight-piece collection dedicated to the founding and current members of AC/DC, as the band turns 50 in November. vinylize.com
As seen on Rihanna, Dua Lipa and Marc Jacobs, model ‘400331’ by Loewe x Paula’s Ibiza has a head-turning concave front. www.loewe.com
Optometrist and lifestyle blogger, Lizzy Yeowart, picks her top eyewear trends to watch out for in the year ahead. See more from Lizzy on her Instagram page at @WHATLIZZYLOVES

OT’s Instagram Trend Watch @ OPTOMETRY_TODAY
‘Thintanium 5501’ Lindberg utilised the latest manufacturing technology to produce a patent-pending Thintanium collection. The ultra-thin design makes for a light, elegant and understated look.
www.lindberg.com


‘STS-30056’
Stepper’s TX5 combines minimal weight with high strength. A unique high-tech moulding process allows for 3D-shaping to help reduce weight and thickness. www.steppereyewear.com



‘Naos’

Cromalyt BetaTitanium by Lool Eyewear is the result of a determination to innovate and develop new technologies, showcased in ‘Naos.’ www.looleyewear.com




Trending now are super-lightweight frames fabricated from innovative materials to produce eyewear that weighs little more than a teaspoon of sugar. This makes for supremely light and seemingly infinitely wearable frames that stay comfortable all day long. While they might feel as though they’re barely there, they do not lack aesthetic impact.







Sense Medical was formed out of a UK subsidiary for theJapanese company, Kowa February 2023 marked the start of a distributorship for Canon Medical ophthalmic eye care products in the UK and Ireland
Sense Medical is certified to ISO 13485 in Medical Devices Quality Management Systems.
The product we launched in September, the Xephilio OCT-R1, will revolutionise two key markets: diabetic eye screening, and High Street optometry. Over the last few years, Canon has developed an optical coherence tomography (OCT) device that can do everything in one smaller footprint device that is easy to use.


Optometry practices don’t have the resource to spend a lot of time training individuals. What is needed is a product that will take care of everything. Canon’s artificial intelligence (AI) technology is going to be a gamechanger in eye care. Utilising this technology to make clinical diagnoses, they will be able to spend more time with their patient.
Do you see more of a role for AI in eye care?
AI is already in the vast majority of our technology, from MRI and CTscans to eye care. We have products that can take




non-invasive OCT-A images and make an average of 800 scans captured to produce the best scan possible, removing the noise and disturbance that might occur during the acquisition. But we want to take AI one step further.
What is the biggest opportunity you see?
We are excited about what the future of AI can bring about. We are also excited to grow the market with Canon.
What are your aims for the next year?
We are investing in headcount and hiring more clinical engineers. We find that a client in a hospital, screening site, or practice, may have a technical challenge, but when engineers arrive, they may ask clinical questions that arise in their use of the device. We want our engineers to be able to answer both, which makes a unique hybrid of technical support staff who can work between technical support and translation of clinical knowledge.
Sense Medical was formedOT looks at the value that OCT can provide for optometrists supporting patients with diabetes, and the importance of routine appointments alongside the national screening programme
The number of people living with diabetes is thought to have topped five million for the first time this year, analysis by Diabetes UK found.

Routine eye examinations form a core part of managing the condition, and optical coherence tomography (OCT) can be a tool in the optometrist’s belt for observing changes and providing reassurance.
The diabetic eye screening programme began in England in 2003, reaching national coverage in 2008, and while it is important that patients participate, ensuring they maintain routine eye tests is crucial.
Sharon Ormonde, Optos sales director for Northern Europe, told OT: “Optometrists often tell us that patients who live with diabetes may decline enhanced tests (such as combined OCT and ultra-widefield imaging) on the basis that they have already undergone their diabetic screening, assuming this includes a thorough assessment of eye health.”
Integrating OCT into routine sight testing in practice can help to provide a more complete picture, with optometrists seeking a more holistic view of the eye.
Ormonde shared: “Optometrists frequently find themselves explaining this distinction to patients in their clinics.”
As a potential aid supporting early diagnosis, scans could provide reassurance.
Ormonde highlighted: “If a patient has a fundus image and an OCT, the optometrist can show them the back of the eye and explain what they are looking for. This offers all patients a peace of mind that they have had the most thorough review of their eye health possible (whether or not they are living with diabetes).”
Claire Martin, head of strategy and marketing for ophthalmic diagnostics for Zeiss, emphasised that screening services “only take a basic visual acuity, without IOP or a slit lamp examination, and rarely include an OCT scan.”
Modern OCT technology is able to diagnose diabetic macular oedema (DME) with a high level of accuracy, Martin shared, using “near micron accurate, threedimensional measurements of the retina.”
For patients receiving a sight test in practice, Martin said: “All published studies have agreed that completing a separate OCT alongside colour fundus gives the best results for early detection of diabetic retinopathy,” adding that 3D OCT scans provide the most accurate result for DME alongside the annual diabetic eye screening. Using OCT in routine appointments can support the detection of other conditions, such as glaucoma or AMD. In addition, tools like the Cirrus 6000 offer a wellbeing report with an overview of the retina and RNFL, which could be taken to the next screening.
Emmeline Webb, clinical sales specialist for Heidelberg Engineering, said: “Having an OCT available during a routine sight test would benefit the patient by offering early reassurance or diagnosis regarding any ophthalmic concerns caused by diabetes.
“Images could also be used as a visual tool for the patient, helping them to understand how their diabetes can be affecting them as an individual.”
A variety of factors can affect an individual’s care, Webb said: “Offering more information and advice to the patient could allow them to feel more confident regarding the management of their diabetes, which could help to improve their overall mental health and wellbeing.”
Using fundus photography and OCT images as a teaching tool can support a patient’s knowledge of their condition, and “this also helps them understand how they are being affected directly, as they can see visual changes.”

Manufacturers highlighted the drive to see more patient care delivered closer to home.
“There is a drive to shift patient care increasingly towards community settings,” Ormonde said.
Initiatives vary across healthcare systems, but technology can provide the information needed to help detect changes earlier, enable timely interventions, and improve outcomes.
Zeiss’ Martin noted that patients can fall between the screening service and hospital eye service: “not needing treatment but needing more advanced and accurate images taken than two-dimensional colour fundus.”
“Community optometry with OCT diagnostics will be able to test and review patients that need repeatable OCT to confirm whether the patient’s diabetic retinopathy is stable or improving with the ability to quickly refer patients back to the hospital eye services when needed,” Martin added.
Elizabeth Woodstock, clinical sales specialist for Heidelberg Engineering, commented: “Building a strong relationship between primary and secondary care can be a beneficial solution for both parties, ultimately improving the accessibility of timely care for patients with various eye disease.”
“Moving forward, I anticipate that the role of OCT imaging will continue to expand in community optometry, with an OCT device being an invaluable asset to any practice,” she concluded.

In 2007, after being in practice for 20 years, I was looking for something new. My boss said, ‘I’m thinking of opening a fourth practice. Do you want to go into partnership?’ I thought, ‘well, I am looking for a challenge.’
At the same time, I got a letter from Aston University, saying a remote doctor of optometry programme was launching. I thought, ‘this is exactly the challenge I was looking for.’ But we’d already signed the lease. I signed up to do the doctorate too.
The practice consumed my whole life. Even when I wasn’t there, I was worrying about it. I know it’s normal, but I wasn’t cut out for it.
Within 10 months, Specsavers and Boots
Opticians opened. The town went from three practices to six. Then, we had the financial crash.
It was costing hundreds of pounds a day just to open the door. Some days, we’d only sell a lens cloth and make a profit of 80p. It got to the point where we had to rent our family home to PhD students.
Four years in, I said, ‘I can’t do this anymore.’ My partner took over for the final year, before we could enact our break clause. For me, stepping away was worth it. It’s hard to describe the relief. I hated the

management and marketing. I wanted to do a good job of looking after patients. It’s hard to balance that when you’re worried about paying the bills.

I finished the doctorate in 2012. The practice’s failure drove me. Had the letter arrived from Aston a few months prior, I wouldn’t have opened the practice. I just knew that the doctorate was the start of something new, so I was channelling my angst into completing it. It was a six-year programme and I’d done it in three and a half, despite also teaching and working six days in the practice.
The experience taught me resilience, and that, to find out what you do like, sometimes you have to work out what you don’t. It’s okay to admit you’re not good at something.
We’re now 10 years on. Almost every day, I’ll walk past the practice and think about how horrible that time was. But then, I remember that I’m not there now, on a Saturday at 8pm, trying to sort out everything that didn’t get done in the week.
Closing the practice was absolutely a positive. I can understand why people would regard it as a failure. But I don’t know how you could define stepping away from something that you hate, to move on to something that you love, as anything but a success.
OT clinical editor, Dr Ian Beasley, on why cutting his losses after five years as a practice owner was the best decision for his mental health
I COULDN’T LIVE WITHOUT…
Due to our expansionwe're lookingfor talented optometristswho share our passionfor patient care. At SpaMedica, you'll benefit from fantastic training and professional development opportunities and work with some of the UK's leading ophthalmologists, nurses, and HCTs.



You'llbe GOCregistered,with at least 12 months' post-registrationexperience- we providefull training so previoushospitalexperienceisn't required.

You'llbe someonethat enjoysvariety,is calm under pressure,great at problemsolvingand is willingto go the extra mile to providethe best serviceand advicefor our patients.
SCANTHE QR CODETO FIND OUT MORE...










17th October 2023 • from 5pm (CPD Lecture & Workshop from 7pm) Knebworth House & Barns, SG3 6PY
The new Clinical Eye Tracker SL builds on the success of the original system which is in use in more than 300 practices and clinics worldwide.
The software links with the new Tobii SL eye tracking device to provide faster sample rates, more accurate recordings and pupillometry.



The software includes a wide range of new tests and features to provide the clinician with a user friendly and affordable tool for assessing eye movements, eye tracking, binocular vision and pupil responses.
"The originalClinicalEyeTracker FIXATIONANALYSIS was amazing- this is even better!"







There is a crisis in primary care. A lot of work is being done to improve integration between primary and community care, and there is a lot of focus on dentistry and GPs, but not enough emphasis being put on optometry.

The membership of the AOP is the most important aspect of why we come to work every day – to represent the optometrists working within the UK. Ultimately, we want to raise the profile of their work within the primary care network. We feel that we are in the position to be the first port of call for ministers and policy makers, to provide intel on what optometrists in the UK are really feeling.
We’ve been working to engage political stakeholders in all the campaigns the AOP has been running. For example, with our Sight for SEN campaign, raising awareness of the need for a long-term commitment to the Special School’s Eye Care Service, we wrote to every MP who has a special school in receipt of the service in their constituency, as well as any relevant health ministers and shadow ministers to bring awareness to the scheme. We contacted 37 MPs in total and took a very individualised approach to each letter we sent, including specific information about their constituency, and we achieved a great impact.
NAME:
Freya StentonROLE:
AOP external affairs officerBy the end of autumn, we will have attended three party conferences: Conservative, Labour, and Liberal Democrats.
We wrote to more than 100 MPs inviting them to meet with us at the conferences to discuss our Sight Won’t Wait campaign, and three
‘quick wins’ that the next Government could achieve to help reduce ophthalmology backlogs. These proposed quick wins include: greater IT connectivity between primary and secondary care, increasing the diagnostic role of optometrists in community care to reduce expanding NHS backlogs in ophthalmology, and elevating the prescribing powers of optometrists to alleviate pressure on GP services and secondary care.
On a daily basis we monitor critical debates, as well as oral and written questions that are submitted to government. We engage our current relationships with MPs to ask questions of ministers and government departments and put pressure on the health department to implement necessary changes to ensure optometrists are given the resources and funding they need to do the amazing work they do every day.
It’s easy for members to get in touch with their MP. Each Member of Parliament has their own website, and also has a profile on the UK Parliament website, which will outline their contact details and any roles they are currently undertaking in Parliament. Anyone who does not know their MP can type their postcode into the UK Parliament website to find their representative. It is also possible to see an MP’s voting record, either on their UK Parliament profile, or on the website www.theyworkforyou. com. This can be a great indication of whether they are representing your views.
MPs can be contacted via email, phone, or letter. MPs also hold surgeries in their constituencies, so members could arrange an appointment to discuss issues face-to-face. The AOP has some resources that can help members to get in touch with their MPs. For example, we have a template letter available for download on the Sight for SEN campaign website. All members need to do is add in some extra information, and then send it to their MP.
One thing I would personally like to do is engage MPs in local optometry – encouraging them into the constituencies to meet optometrists and see the work that they do. We encourage any members interested in hosting an MP visit to get in touch.
It is your democratic right to vote in elections as a resident of the UK. Whether or not your MP is a member of a political party that you personally subscribe to, their primary role is to represent the views of their constituents.
Interested in hosting your MP for a practice visit? Get in touch with the AOP team: communications@aop.org.uk

Teams from the AOP have been visiting optometry schools across the UK, discussing what it means to be a member with first-year studentswww.aop.org.uk/your-career/students
In this year’s Tabbie Awards, OTreceived an honourable mention for its June/July 2022 Inthedarkcover story. Written by Selina Powell, it explored the impact of delays on patients waiting for cataract surgerywww.optometry.co.uk

In case you missed it OT has launched a new resource to support practice team training. The four-module package has been supported by Johnson & Johnson Visionwww.optometry.co.uk/ practiceteamtraining
Sight won’t wait Autumn/Winter
The AOP launches the second phase of its campaign this October. See more at: www.aop.org.uk/sightwontwait
Westminster Eye Health Day 1 November
As a partner in TheEyesHaveit, the AOP will highlight the importance of eye health with MPs: https://eyeshaveit.co.uk
AOP Council meeting 1 November
The AOP Council will gather in London for the third meeting of the year, to discuss key topics in optometry. Find your Councillor here: www.aop.org.uk/councillors

Ò Whether or not your MP is a member of a political party that you personally subscribe to, their primary role is to represent the views of their constituents
Freya Stenton, AOP external affairs officer


I’m the sort of person who likes to know how things work. It keeps me up at night when I have a problem I can’t solve, and there’s not much I like doing more than taking something apart, fixing it, and putting it back together.

Right now, on my work bench I have a set of bike pedals stripped to their individual pieces that I sort of regret unscrewing – more pieces than I was expecting fell out. However, the consequences of that are minimal – I’ve read the manual, so with some time and patience they should be back in full working order. Perfection can be the enemy of good in that scenario – perhaps all they needed was to be cleaned and lubricated. In my clinical practice though, what I’ve described isn’t an appropriate way to work – the consequences of getting something wrong could be significant, so trying things you’re not experienced in isn’t safe.
I qualified as an IP optometrist over a decade ago, and in that time the way I treat eye conditions has changed – but that doesn’t mean I know everything, and it is still important for me to reflect on treatments provided – especially when it hasn’t gone as expected.
I have seen a few patients recently where the treatment required had to be changed after a few days. I struggle to say that those treatments were a ‘failure’ – but it is important to know what you don’t know and seek advice if you’re not sure. Sometimes, with hindsight, I would have initiated that treatment sooner, but sometimes it was just the natural course of the condition when what was reasonable treatment, using my experience and guidance, needed to be escalated. It isn’t appropriate to just ‘have a go,’ but reflecting on your practice and using that to improve is part of being a professional. One benefit of experience is being able to tell patients what to expect because I’ve seen it before (and I write that down). That way you can modify the treatment at an early stage if required – and you’re also telling the patient that the future can be difficult to predict, but this is how we’ll manage any issues. I hope that I spend the rest of my career, not making mistakes, but reflecting on the treatment I provide and using that learning to improve what I do.
Optometrist and AOP Councillor, Kevin Wallace, on reflecting, learning and advancing clinically
“
Reflecting on your practice and using that to improve what you do is part of being a professional














MyDay®toric has increasedits parameter range to cover 95% of the astigmaticpopulation:























The only one-day toric lens that offers around-the-clock axes across all cylinder powers and a core range from +8.00 to -1 0.00DS.t Powered by Aquaform®Technology.




Optimised Torie Lens Geometry'."
We've


My ay'dailydisposable toric 30~hydr09"(()11tolCtltnSt5

toric has the largest number of prescription options of any one day toric contact lens. t Around the clock axes in 10° steps from piano to -10.00DS, and from +1.25D5 to +8.00DS in cylinder powers -0.75DC, -1.25DC, -1.75DC, and -2.25DC in cylinder powers. 1. CVI data on file 2021. Based on prescription option combinations (sph, cyl, axis) available across all daily disposable toric soft lenses from CooperVision®,Johnson and Johnson Medical Ltd.® Bausch & Lomb Inc.®and Alcon Inc.®in UK, France, Germany and Italy Dec 2021. Cosmetic & Photochromatic Cls not included. Multiple base curve variants not included. 2. CVI data on file, 2021. Rx coverage database n-83,540 eyes; 14 to 70 years.
made our one-day contact lensesplastic neutral through our partnership with Plastic Bank®.One-day contact lensesare defined as orders placed by customers for those products and includesproducts sold and distributed by CooperVision®in the United Kingdomand Ireland. Plastic neutrality is establishedby purchasingcredits from Plastic Bank®. A credit representsthe collectionand conversionof one kilogramof plasticthat may reachor be destinedfor waterways. CooperVision®purchasescredits equalto the weight of plastic in our one-day contact lensordersin a specifiedtime period. One-day contact lensplasticis determined by the weight of plasticin the blister.the lensand the secondarypackage(outer carton). includinglaminates,adhesives,and auxiliary inputs (e.g. ink).